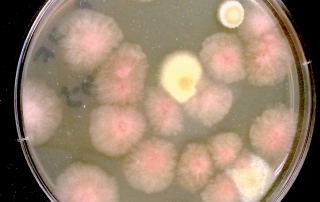
Exploring the Future of Embedded Technology

Our commercial and very eligible authors can extensive your entire write down my essay needs. Get high-quality Garageband for Windows writing for almost any sensible value.
Inside GAC Toyota Zhuzhou Jiucheng 4S Store: A Customer-Focused Experience
Stepping into the Future of Car Buying in Zhuzhou The automotive retail landscape is constantly evolving, and dealerships are adapting to meet the changing needs and expectations of customers. One dealership that appears to be leading the way in Zhuzhou, [...]
The Algorithmic Tightrope: Navigating the Nuances of AI-Generated Content Authenticity
Unmasking the Machine: A Practical Guide to Identifying AI-Authored Content Artificial intelligence is no longer a futuristic fantasy; it's a present-day reality shaping how content is created, distributed, and consumed. From drafting emails to scripting entire novels, AI tools offer [...]
The Evolving Landscape of HigherEdLeadership: Profiles in Innovation and Resilience
Navigating the Future of Higher Education: A Leadership Perspective The world of higher education is in constant flux, demanding a new breed of leader capable of navigating complex challenges and fostering innovation. From shifting demographics and technological advancements to evolving [...]
Beyond the Podium: Humanizing Leadership in Higher Education
The Evolving Landscape of University Leadership Higher education stands at a critical juncture. Navigating disruptive technologies, shifting student demographics, and evolving societal expectations demands a new breed of leader – one who is not only academically accomplished but also deeply [...]
Beyond Diet and Discipline: Unlocking the Real Reasons Behind Weight Gain
Decoding the Mystery of Unexplained Weight Gain It's disheartening: you're eating healthy, exercising regularly, yet the weight won't budge. While it's easy to blame a lack of willpower or hidden calories, the truth is often more complex. Your body's intricate [...]
Beyond the Textbook: Unconventional Leadership Styles Shaping Higher Education
A New Era of University Leadership The traditional image of university leadership is fading. Today's higher education landscape, marked by diverse student populations, technological leaps, and heightened expectations, calls for leaders who are agile and inventive. This article spotlights university [...]
Beyond the Podium: Unveiling the Leadership Philosophies of University Trailblazers
Beyond the Podium: Unveiling the Leadership Philosophies of University Trailblazers Universities, vibrant hubs of learning and groundbreaking discoveries, are guided by leaders whose foresight and commitment shape tomorrow. Though their scholarly accomplishments often dominate the spotlight, examining their leadership approaches [...]
Venezianico Arsenale: A Detailed Look at This Emerging Watch Brand
Unveiling the Venezianico Arsenale: A Detailed Examination The watchmaking landscape is dynamic, witnessing the rise of innovative brands alongside established names. Venezianico, an Italian marque, is making waves with its distinctive designs and dedication to craftsmanship. The Arsenale model, specifically, [...]
Funding the Future of Journalism: Cultivating Talent Through Scholarships and Innovative Support
The Evolving Landscape of Journalism Funding The media landscape is in constant flux. Traditional revenue models are dwindling, and the demand for high-quality, trustworthy journalism is higher than ever. While much discussion revolves around grants, philanthropy, and subscriptions, a crucial [...]
Unlock Your Journalism Dreams: A Guide to Scholarships and Fellowships
Your Path to Becoming a Journalist Starts Here The world of journalism is constantly evolving, demanding skilled and passionate individuals to tell the stories that shape our understanding of the world. But pursuing a career in journalism often comes with [...]
AI-Powered Personalization: Marketing’s New Frontier
Beyond Mass Marketing: The AI Revolution in Customer Engagement The days of one-size-fits-all marketing are numbered. Today's consumers are bombarded with generic ads and irrelevant offers, leading to decreased engagement and wasted marketing spend. Artificial intelligence offers a powerful solution: [...]
Beyond the Hype: Ethical AI Marketing Strategies for Sustainable Growth
The New Marketing Imperative: Ethical AI Artificial Intelligence (AI) is rapidly transforming marketing, offering unprecedented opportunities for personalization and efficiency. However, this technological leap demands a parallel commitment to ethical practices. The focus must shift from simply leveraging AI's capabilities [...]
The Ethical Compass of AI Personalization: Navigating Bias and Building Trust
The Double-Edged Sword of AI-Driven Personalization Artificial intelligence is revolutionizing the digital landscape, offering unprecedented personalization in areas like e-commerce, education, and entertainment. However, this powerful technology comes with significant ethical responsibilities. While personalized AI promises enhanced user experiences and [...]
Beyond the Algorithm: AI Personalization and the Human Connection
Beyond Automation: AI as a Relationship Builder In today's hyper-connected world, generic messaging falls flat. Artificial intelligence is evolving beyond simple task automation to become a powerful engine for understanding and nurturing individual customer relationships. This shift is transforming personalization [...]
Beyond the Podium: Unveiling the Leadership Philosophies of University Trailblazers
Beyond the Public Persona: Leadership in Academia We see them on stage, bestowing degrees, or in the news, celebrating research breakthroughs. But what principles guide the leaders at the helm of our universities? This article looks past the public image, [...]
Beyond Grants: Exploring Diverse Funding Models for Modern Journalism
The Evolving Landscape of Journalism Funding The media landscape is in constant flux, and with it, the traditional models for funding journalism are being challenged and reimagined. While grants remain a vital source of support, relying solely on them can [...]
Venezianico Arsenale: A Hands-On Review and Deep Dive
Is the Venezianico Arsenale Worth the Attention? A Critical Examination The Venezianico Arsenale has generated buzz in watch circles, promising Italian flair coupled with solid mechanics at a reasonable price. But does it live up to the hype? This isn't [...]
Inside the SAIC Audi Nantong Baizun User Center: A Glimpse into the Future of Automotive Retail
Experiencing Automotive Excellence: The SAIC Audi Nantong Baizun User Center The automotive retail landscape is evolving, and SAIC Audi is at the forefront of this transformation. The Nantong Baizun User Center is more than just a dealership; it's an immersive [...]
Google’s Simula: Redefining AI with Synthetic Data and Persistent Agents
The Shifting Sands of AI: Data Design Takes Center Stage The landscape of artificial intelligence is undergoing a profound transformation. It's no longer solely about amassing vast quantities of data and hoping for emergent intelligence. Instead, the focus is shifting [...]
Venezianico Arsenale: A Detailed Hands-On Review
Unveiling the Venezianico Arsenale: A Microbrand Marvel? The world of microbrand watches continues to expand, offering enthusiasts unique designs and compelling value propositions. Among these emerging brands, Venezianico has garnered attention for its distinctive Italian-inspired aesthetics and commitment to quality. [...]
Beyond the Hype: AI and the Evolving Media Landscape in 2024
The Media Industry's AI Infusion: More Than Just a Buzzword The media industry is no stranger to disruption, but the current wave, driven by artificial intelligence (AI), feels different. It's not just about new platforms or content formats; it's a [...]
Beyond Subscriptions: Innovative Funding Models Fueling Modern Journalism
The Evolving Landscape of Journalism Funding The media landscape is in constant flux. Traditional advertising revenue, once the bedrock of journalism, has eroded, forcing news organizations to explore new and innovative funding models. While subscriptions and paywalls remain crucial, a [...]
Uncorking Happiness: A Toast to a Fulfilling Life
The Symphony of Joy: Orchestrating Your Own Happiness Ever felt like happiness is a fleeting visitor, a guest who arrives unannounced and departs just as quickly? What if you could invite happiness to stay, to become a constant companion on [...]
Unlocking Hyper-Personalization: Advanced AI Marketing Strategies Beyond the Basics
Beyond Segmentation: The Rise of Personalized Experiences We've moved past the era of mass marketing. Today, consumers demand experiences tailored to their individual needs. Artificial intelligence (AI) is at the forefront of this shift, enabling marketers to move beyond basic [...]
Adaptive Leadership: Navigating Complexity in Higher Education
The Evolving Landscape of Leadership Styles Leadership is not a one-size-fits-all concept. In today's dynamic world, especially within the complex ecosystem of higher education, the most effective leaders are those who can adapt their style to suit the situation, the [...]
Beyond the Textbook: Unconventional Leadership Styles Shaping Higher Education
The Shifting Sands of University Leadership University leadership is undergoing a profound transformation. The era of purely hierarchical, bureaucratic control is fading. Today's academic leaders face a multifaceted array of hurdles, including dwindling budgets, the relentless march of technology, the [...]
Gazing into the Future: The Standout Watches of Watches & Wonders 2026
A Glimpse into Horological Innovation: Watches & Wonders 2026 Watches & Wonders, the premier global watch event, consistently sets the stage for the future of horology. Looking ahead to 2026, the innovations on display promise to redefine what's possible in [...]
AI’s Paradigm Shift: OpenMythos, Kimi-K2.6, and Grok Redefine the Landscape
A 22-Year-Old's Creation Shakes the AI World The AI landscape is experiencing a seismic shift, driven not just by bigger models, but by smarter architectures, efficient deployment, and a modular approach. At the heart of this revolution is OpenMythos, a [...]
Unlocking Your Potential: A Comprehensive Guide to Journalism Scholarships and Fellowships
Crafting Your Future in Journalism: Funding Opportunities Abound The world of journalism is constantly evolving, demanding passionate and skilled individuals to report, investigate, and inform. However, pursuing a career in this field can be financially challenging. Fortunately, numerous scholarships and [...]
Beyond the Byline: Unveiling the Hidden Benefits of Journalism Fellowships
Beyond the Byline: Unveiling the Hidden Benefits of Journalism Fellowships The glint of a Pulitzer, the weight of a printing press, the relentless pursuit of truth – these are the romanticized images that often accompany the life of a journalist. [...]
Beyond the Ivory Tower: Unveiling the Inspiring Stories of University Leaders
More Than Just Figureheads: The Human Side of University Leadership Universities, often seen as centers of knowledge, are vibrant communities driven by the passion and vision of their leaders. From university presidents to student body representatives, these individuals guide the [...]
Beyond the Ivory Tower: Unveiling the Visionaries Shaping Higher Education
Meet Professor Anya Sharma: A Transformative Force in STEM Education The hallowed halls of academia often conjure images of tradition and unwavering adherence to established norms. Yet, within these institutions, there exists a dynamic group of leaders who are [...]
The Algorithmic Tightrope: Navigating the Ethics and Implications of AI-Generated Content Authenticity
The AI Content Conundrum: Trust, Truth, and the Future of Information Artificial intelligence is no longer a futuristic fantasy; it's a present-day reality rapidly transforming how we create and consume information. AI-powered tools can now generate text, images, and even [...]
The Algorithmic Alibi: Proving Authenticity in an Age of AI-Generated Content
Navigating a World of Synthetic Media The digital landscape is changing rapidly, with AI-generated content becoming increasingly prevalent. This surge challenges our fundamental understanding of authenticity. Trusting what we encounter online is no longer a given. The ease with which [...]
Navigating the Political Media Landscape: A Look at Goldsmiths, University of London’s Media and Communications Programs
The Amplified Echo Chamber: Political Commentary in the Age of Trump The contemporary political media landscape, particularly concerning figures like Donald Trump, is characterized by a phenomenon where commentators' acronyms and sound bites often overshadow substantive analysis. This trend raises [...]
Unlocking Hyper-Personalization: How AI is Reshaping Customer Experiences Through Predictive Empathy
Beyond Personalization: The Rise of Anticipatory Customer Service We've moved past the era of simple personalization. Customers now expect businesses to understand not just their past behavior, but also their future needs. This is where AI-powered anticipatory customer service comes [...]
Equation Leopard Roars into Harbin: A First Look at the BYD Sub-Brand’s Newest Showroom
Harbin Welcomes Equation Leopard: A New Era of Automotive Innovation Harbin, China – The automotive landscape in Harbin is shifting gears with the grand opening of a new Equation Leopard (方程豹) 4S store on the city's busy airport road. This [...]
The Evolving Landscape of HigherEdLeadership: Profiles in Innovation and Resilience
The New Face of Academic Leadership The world of higher education is rapidly changing, calling for leaders who can do more than just manage. Today's HigherEdLeadership demands forward-thinkers who can tackle tough issues, encourage new ideas, and promote a culture [...]
Navigating the Future of Higher Education: Leadership, Innovation, and Human Connection
Reimagining Leadership in Academia Leadership's role in higher education is being redefined. It's no longer about preserving tradition. Leaders now need to be forward-thinkers, innovators, and empathetic mentors, equipped to handle unforeseen hurdles and mold their institutions' futures. This demands [...]
The Ethical Compass of AI Personalization: Navigating Bias and Building Trust
The Human Side of AI: Why Ethics Matter in Personalization Artificial intelligence is rapidly transforming how we interact with the digital world, particularly through personalization. From curated playlists to tailored news articles, AI strives to provide experiences uniquely suited to [...]
Revolutionizing Media: How AI and Emerging Technologies are Reshaping the Industry
The Media Landscape Transformed: A New Era of Innovation The media industry is undergoing a seismic shift, driven by the relentless march of artificial intelligence (AI) and a wave of other emerging technologies. From content creation to distribution and consumption, [...]
AI-Powered Personalization: The Future of Marketing Engagement
Beyond Segmentation: AI's Role in Building Individual Customer Journeys Traditional marketing relies on broad segmentation. AI, however, allows us to transcend these limitations and craft truly individual customer journeys. It's not just about knowing demographics; it's about understanding individual needs, [...]
Elevating Marketing ROI: AI-Powered Personalization Strategies
Beyond Segmentation: The Era of Individualized Customer Experiences Forget generic marketing blasts. Today's consumers demand relevance. They want to feel understood and valued. Artificial intelligence (AI) is no longer a futuristic concept; it's the engine driving a new era of [...]
Leadership Styles in Academia: Profiles of Visionary University Leaders
Navigating the Ivory Tower: A Look at Academic Leadership Leadership extends far beyond the business world; it's a vital force within universities. Beyond research and education, strong leadership is essential for sparking innovation, propelling advancement, and cultivating tomorrow's thought leaders. [...]
Beyond the Textbook: Unconventional Leadership Styles Shaping Higher Education
Reimagining Academic Leadership: Stepping Outside the Lines Universities and colleges, often seen as bastions of tradition, are in fact hotbeds of change, particularly when it comes to leadership. While servant and transformational leadership theories are frequently examined, a new breed [...]
Unlocking Opportunities: A Deep Dive into Niche Media Fellowships
Beyond the Headlines: Exploring Specialized Media Fellowships In the ever-evolving media landscape, the pursuit of impactful storytelling often requires specialized knowledge and resources. While general media fellowships provide invaluable support, niche programs are emerging as powerful catalysts for journalists and [...]
Unlocking Journalistic Potential: Fellowships as Launchpads for Innovation and Impact
Beyond the Byline: How Journalism Fellowships Are Shaping the Future of News In an era defined by rapid technological advancements and evolving media landscapes, the role of journalism is more critical than ever. But how do journalists stay ahead of [...]
Journalism’s Next Chapter: Cultivating a Sustainable Funding Ecosystem Through Education and Innovation
Beyond Subscriptions: A New Era for Journalism Funding The media landscape is in constant flux. Traditional revenue models for journalism are under immense pressure, forcing news organizations to explore uncharted territories for financial sustainability. While subscriptions, memberships, and philanthropic donations [...]
Agent Swarms: The AI System Redefining Team Collaboration and Automation
The Dawn of Agent Swarms: AI That Works Like a Team The world of Artificial Intelligence is constantly evolving, and recent advancements are hinting at a paradigm shift. Agent Swarms technology represents a fundamental change in how AI can approach [...]
Unlock Your Potential: A Comprehensive Guide to Journalism Scholarships and Fellowships
Dreaming of a Career in Journalism? Funding is Within Reach. The world of journalism is dynamic and ever-evolving, demanding skilled and passionate individuals to tell the stories that shape our understanding of the world. However, the path to becoming a [...]
Beyond the Screen: How Emerging Technologies are Reshaping the Media Landscape
The Algorithmic Echo Chamber: Navigating the Future of Media Consumption The media landscape is in constant flux, driven by rapid technological advancements and evolving consumer habits. From AI-powered content creation to immersive virtual experiences, the way we consume and interact [...]
Equation Leopard Roars into Harbin: A First Look at the Airport Road 4S Store
Harbin Welcomes the Equation Leopard: A New Era of Automotive Innovation The automotive landscape in Harbin is shifting gears, and at the forefront of this change is the arrival of the Equation Leopard. The brand's new 4S store on Airport [...]
The Ethical Tightrope: Navigating AI Content Authenticity in Education
The Rise of AI in Academia: A Paradigm Shift Artificial intelligence is no longer a futuristic concept; it's a present-day reality deeply impacting education. While AI offers incredible opportunities to personalize learning and automate administrative tasks, it also presents significant [...]
Breaking Through Weight Loss Plateaus: Common Mistakes and How to Overcome Them
Facing the Plateau: A Natural Part of Weight Loss Starting a weight loss program signifies dedication to a better self, yet the road isn't always smooth. Expect ups and downs, with plateaus being a common and normal occurrence. Recognizing the [...]
Navigating the Murky Waters: Ethical Considerations in AI Content Creation
The Rise of the Machines... and Their Words Artificial intelligence is no longer a futuristic fantasy; it's a present-day reality reshaping how we create and consume content. From composing compelling ad copy to drafting legal documents, AI-powered tools offer unprecedented [...]
Beyond Algorithms: The Ethical Frontier of AI-Powered Personalization
The Promise and Peril of Tailored Experiences Artificial intelligence is revolutionizing how businesses connect with their customers, moving beyond simple segmentation to create bespoke experiences. Sophisticated machine learning models analyze vast datasets to predict individual preferences and behaviors, promising increased [...]
Equation Leopard’s Harbin Debut: A Glimpse into BYD’s Bold New Off-Road Venture
Harbin Welcomes the Equation Leopard: A New Era of Off-Roading The chill of Harbin couldn't freeze the excitement surrounding the arrival of BYD's Equation Leopard. The newly opened 4S store on Harbin Airport Road is buzzing, signaling a significant step [...]
Conquering Weight Loss Plateaus: Strategies for Continued Success
Navigating the Weight Loss Plateau It's disheartening when your weight loss journey hits a snag. You've been dedicated to your diet and exercise, enjoying steady progress, only to find the scale stubbornly resistant. Realize that plateaus are a common, expected [...]
Beyond Grants: Unconventional Funding Avenues for Modern Journalism
Beyond Grants: Unconventional Funding Avenues for Modern Journalism In an era where traditional revenue models are crumbling, journalists and media organizations are constantly seeking innovative ways to finance their work. While grants remain a vital source of funding, relying solely [...]
Beyond Algorithms: The Ethical Compass of AI-Powered Personalization
The Rise of the Algorithmic Butler: Convenience at What Cost? Artificial intelligence is rapidly evolving from a futuristic fantasy to an everyday reality, offering the promise of hyper-personalized experiences across various sectors. From curated news feeds to tailored product recommendations [...]
Revolutionizing Media: How AI and Emerging Tech are Reshaping the Industry
The Dawn of a New Media Landscape The media industry is undergoing a seismic shift, driven by rapid advancements in artificial intelligence (AI) and emerging technologies. From content creation and distribution to audience engagement and monetization, these innovations are not [...]
Beyond Grants: Unconventional Funding Avenues for Modern Journalism
Beyond Grants: Unconventional Funding Avenues for Modern Journalism In the ever-evolving media landscape, securing funding remains a persistent challenge for journalists. While traditional grants and philanthropic donations continue to play a vital role, exploring alternative and innovative funding models is [...]
Leadership Styles in Academia: Leading with Vision and Empathy
The Shifting Sands of Academic Leadership Universities today are intricate systems, requiring leaders who go beyond simple administration. Today's academic heads need to be forward-thinkers, strategic planners, and, most importantly, empathetic individuals who can address the varied needs of faculty, [...]
Beyond the Textbook: Unveiling the Hidden Leadership Styles Shaping Higher Education
Hidden Influencers: Leadership's Quiet Role in Academia Leadership extends far beyond executive suites and strategic documents; it encompasses influence, motivation, and adeptness in navigating intricate systems. Within the academic sphere, leadership emerges in various forms, significantly impacting students and scholarly [...]
Beyond the Ivory Tower: Unveiling the Visionaries Shaping University Futures
University Trailblazers: Steering Institutions Toward Tomorrow More than just places of learning, universities are evolving environments molded by the passion and leadership of dedicated individuals. From presidents to student representatives, these leaders confront intricate issues and empower the students of [...]
Beyond the Ivory Tower: Unveiling the Personal Stories of University Leaders
Beyond the Office Door: Personal Journeys of University Presidents and Deans Universities thrive on the vision and hard work of dedicated leaders. But what about the people behind the impressive titles? This article explores the personal stories of several pivotal [...]
Unlocking Opportunities: A Deep Dive into Specialized Media Fellowships
Beyond the Basics: Exploring Niche Media Fellowships Media fellowships are often seen as stepping stones for journalists and content creators, offering invaluable resources, mentorship, and funding. However, beyond the well-trodden paths of general journalism fellowships lie a wealth of specialized [...]
Beyond Grants: Unconventional Funding Models Fueling Journalistic Innovation
The Evolving Landscape of Journalism Funding The media industry is in constant flux, and with it, the ways journalism is funded are also rapidly changing. While traditional sources like advertising revenue dwindle, new models are emerging, driven by technological advancements, [...]
Anthropic’s Claude 4.7: A Leap Forward and a Glimpse Behind the Curtain
Claude 4.7 Arrives: More Than Just Another Model Update Anthropic has just unleashed Claude Opus 4.7, and the ripples are spreading far beyond the usual tech circles. This isn't just a minor iteration; it's a substantial upgrade that significantly bolsters [...]
Unlocking Your Potential: A Comprehensive Guide to Journalism Scholarships and Fellowships
Your Path to Becoming a Journalist: Funding Your Dreams The world of journalism is constantly evolving, demanding skilled and passionate individuals to report on the stories that shape our society. However, pursuing a career in this field can be financially [...]
Unlocking Journalistic Potential: Fellowships Beyond the Obvious
Beyond the Byline: Finding Your Niche in Journalism Fellowships The world of journalism is constantly evolving, demanding adaptability and specialized knowledge. While traditional reporting remains vital, new avenues for storytelling and information dissemination are emerging. This creates a landscape ripe [...]
Revolutionizing Media: AI, Cloud, and the Fight for Freedom in the Digital Age
The Media Landscape Transformed: A Convergence of Innovation and Challenges The media industry is undergoing a seismic shift, propelled by rapid technological advancements and evolving consumer habits. Artificial intelligence (AI), cloud computing, and immersive technologies are no longer futuristic concepts [...]
Leadership in Academia: Profiles of Visionaries Shaping Higher Education
University Leadership: More Than Just Management Leadership in academia extends far beyond administrative duties. Within the vibrant environment of a university, leadership takes many shapes, from the Chancellor's strategic vision to the individual guidance offered in a professor's office. It's [...]
Beyond the Textbook: Unconventional Leadership Styles Shaping Higher Education
Rethinking Academic Leadership: Stepping Outside the Box Universities, often perceived as guardians of tradition, are quietly undergoing a leadership transformation. While conventional authority structures persist, a fresh wave of academic leaders is adopting novel approaches to tackle the intricate issues [...]
The Ethical Frontier: AI-Powered Personalization and the Preservation of User Autonomy
The Double-Edged Sword of AI-Driven Personalization Artificial intelligence is rapidly changing how we interact with the digital world, offering tailored experiences designed to cater to our individual preferences. From curated music playlists to customized news feeds, AI-powered personalization is becoming [...]
Beyond the Algorithm: AI-Powered Personalization and the Human Touch
Beyond One-Size-Fits-All: The Rise of Personalized Experiences Remember the days of mass marketing, where everyone saw the same advertisement, regardless of their individual interests? Those days are fading fast. Today's consumers expect more; they demand experiences tailored to their unique [...]
Beyond the Podium: Unveiling the Leadership Philosophies of University Trailblazers
Unveiling the Leadership Secrets Behind Academic Success Universities are typically viewed as centers for research and education. However, the success of any university hinges on the dedicated leaders who guide it. These individuals, ranging from presidents to student representatives, mold [...]
Beyond the Ivory Tower: Unveiling the Visionaries Shaping Higher Education
Academic Leadership: A Fresh Look Universities are dynamic hubs, propelled by the vision and commitment of extraordinary leaders. More than just administrators, these individuals are forging the future, nurturing intellect and spearheading pioneering research. This article explores the profiles of [...]
Beyond Grants: Exploring Diverse Funding Models for Modern Journalism
The Evolving Landscape of Journalism Funding The media landscape is in constant flux. Traditional revenue streams are dwindling, and the need for independent, high-quality journalism is more critical than ever. While grants remain a vital source of funding, relying solely [...]
Hublot Unico: Misunderstood Innovator or Overpriced Hype? A Watchmaker’s Deep Dive
Switzerland – Hublot. The mere mention of the name ignites passionate arguments among watch lovers. Is Hublot a daring innovator redefining watchmaking, or just a master of marketing creating inflated desire? After a 15-year break from the brand, one watchmaker [...]
The Robot Revolution is Accelerating: From AI War Machines to Humanoid Assistants
The Dawn of the Robot Age The future, once a distant concept, is rapidly materializing before our eyes. A confluence of advancements in artificial intelligence, robotics, and automation is driving a transformation across industries and even warfare. From China's development [...]
Nut Studio: Deploy Your First AI Agent in Under 3 Minutes (No Coding Required)
Tired of AI Setup Headaches? Nut Studio Offers a 3-Minute Solution The promise of AI agents – personalized assistants automating daily tasks – is incredibly appealing. But the reality often involves complex setups, coding nightmares, and cloud account integrations that [...]
Revolutionizing Media: How AI and Emerging Technologies Are Reshaping the Industry
The Media Landscape Transformed: Riding the Wave of Innovation The media industry, a dynamic and ever-evolving realm, stands on the precipice of a profound transformation. Driven by the relentless march of artificial intelligence (AI) and a suite of emerging technologies, [...]
AI Content Authenticity: The Human-AI Collaboration Imperative
The Authenticity Crisis: Why AI Alone Can't Be the Answer Artificial intelligence is rapidly changing how we generate content, offering unprecedented speed and efficiency. However, this revolution brings a significant challenge: how do we ensure the content's authenticity and trustworthiness? [...]
Navigating the Murky Waters: AI Content Authenticity and the Human Touch
Beyond Detection: Embracing the AI-Human Content Synergy The narrative surrounding AI and content often revolves around detection – identifying what's 'real' versus 'artificial.' However, a more productive lens focuses on the collaborative potential. Instead of viewing AI as a threat [...]
HigherEdLeadership: Cultivating Innovation Through Emotional Intelligence
Leadership Evolved: Emotional Intelligence in Higher Education The world of higher education is undergoing a significant transformation. While academic excellence and strategic thinking remain crucial, the most impactful leaders in higher education today demonstrate a strong grasp of emotional intelligence [...]
Reimagining HigherEdLeadership: Profiles of Visionaries Shaping Tomorrow’s Universities
The Evolving Role of HigherEdLeadership Higher education is experiencing a profound evolution. Universities are transforming from traditional learning environments into vibrant centers of innovation, research, and community involvement. This evolution necessitates a new kind of leader – individuals with academic [...]
Unlocking Your Potential: A Deep Dive into Specialized Media Fellowships
Beyond the Basics: Exploring Niche Media Fellowship Opportunities Media fellowships offer invaluable opportunities for journalists and storytellers to hone their skills, explore critical issues, and connect with industry leaders. While general fellowships provide broad training, specialized programs cater to specific [...]
Unlocking Journalistic Potential: A Guide to Fellowships Beyond the Headlines
Beyond the Byline: Finding Your Niche Through Journalism Fellowships The world of journalism is a dynamic landscape, constantly evolving with new technologies and shifting public interests. For aspiring and seasoned journalists alike, staying ahead requires continuous learning and adaptation. While [...]
Beyond Grants: Innovative Models for Journalism Funding in the Digital Age
The Shifting Sands of Journalism Funding The media landscape is in constant flux, and with it, the traditional models for funding journalism are undergoing a radical transformation. Where once advertising revenue and print subscriptions reigned supreme, today, news organizations are [...]
Google Unleashes Gemini’s AI Power, Transforming Chrome into an AI Beast
Gemini's Grand Expansion: Beyond the Chatbot Google isn't just tweaking its AI models; it's orchestrating a full-scale Gemini ecosystem. Recent developments signal a strategic push to integrate Gemini across various platforms, turning it into a versatile tool that extends far [...]
Unlocking Your Potential: A Guide to Journalism Scholarships and Fellowships
The Quest for Funding: A Journalist's Guide to Scholarships and Fellowships Aspiring journalists face a unique set of challenges. Beyond honing their skills in reporting, writing, and ethical storytelling, they often grapple with the financial realities of pursuing higher education. [...]
The Media Revolution: AI, Cloud, and the Fight for Digital Freedom
Navigating the Digital Transformation: A New Era for Media The media landscape is undergoing a seismic shift, driven by relentless technological innovation. Artificial intelligence (AI), cloud computing, and evolving consumer habits are converging to reshape how content is created, distributed, [...]
Article – April 15, 2026
The State of Digital Communication in 2026 April 15, 2026, marks a significant point in the evolution of digital communication. We've moved far beyond simple text-based interactions and now navigate a complex landscape of multimedia, AI-driven content, and personalized experiences. [...]
AI-Powered Marketing: Elevating Customer Experience Through Hyper-Personalization
Forget generic marketing blasts. Today's consumer demands experiences tailored just for them. Artificial intelligence (AI) offers the potential to deliver this hyper-personalization, but many businesses struggle to move beyond the hype. This article cuts through the noise, providing actionable strategies [...]
Unlocking Hyper-Personalization: AI-Driven Strategies for Marketing Success
From Data to Dialogue: How AI Fosters Meaningful Marketing Artificial intelligence isn't just about automating tasks anymore; it's about forging genuine connections with customers. While AI's ability to streamline processes like content scheduling and basic ad targeting is well-established, its [...]
Leadership Styles in Academia: Shaping the Future of Higher Education
Leadership Beyond the Classroom: Influencing Higher Education Leadership extends far beyond corporate settings. It flourishes, perhaps even more critically, within universities. Academic leaders exert significant influence, guiding research directions and fostering future innovators. But which leadership approaches are most effective [...]
Beyond the Textbook: Unearthing Uncommon Leadership Styles in Academia
Rethinking Leadership in Higher Education The image of academic leadership often involves venerable professors delivering lectures. However, contemporary universities demand a broader spectrum of leadership approaches to flourish. From innovative provosts to engaged student representatives, effective leadership is essential for [...]
Ethical Considerations in AI-Powered Personalization: Navigating the Minefield
Personalized Experiences: A Tightrope Walk Artificial intelligence (AI) is revolutionizing how businesses interact with their customers, offering unprecedented opportunities to create personalized experiences. From tailored content and product recommendations to targeted advertising, AI-driven personalization promises to boost customer engagement and [...]
Beyond Algorithms: The Ethical Frontier of AI-Powered Personalization
The Promise and Peril of AI-Driven Personalization Imagine a world perfectly tailored to your needs and desires. That's the tantalizing promise of AI-powered personalization. Forget generic recommendations; we're talking about algorithms that analyze your digital footprint to predict your next [...]
Beyond the Bio: Unveiling the Leadership Styles of University Trailblazers
The Personal Touch in University LeadershipnUniversities thrive on groundbreaking ideas, guided by leaders who influence both the institution's future and the experiences of students and professors. We often celebrate their achievements, but the individual stories, leadership methods, and core beliefs [...]
Beyond the Ivory Tower: Illuminating the Leadership of Academia’s Finest
Unveiling the Architects of Academia Universities, those venerable institutions of learning and discovery, are intricate systems guided by a spectrum of leaders. From the Principal to student representatives, these figures mold the academic environment and impact the futures of numerous [...]
Unlocking Journalistic Potential: Beyond Traditional Funding Models
The Evolving Landscape of Journalism Funding In an era defined by rapid technological advancements and shifting media consumption habits, the traditional models of journalism funding are facing unprecedented challenges. The decline in print advertising revenue, coupled with the rise of [...]
Hublot Unico: A Watchmaker’s Honest Assessment of Design, Quality, and Movement
Beyond the Hype: A Watchmaker's Deep Dive into the Hublot Unico Hublot. The name itself evokes strong reactions in the watch community, often polarizing opinions. Are they masters of innovation or riding a wave of brand recognition? This article presents [...]
Unlocking Opportunities: A Guide to Niche Media Fellowships
Beyond the Headlines: Finding Your Perfect Media Fellowship In the ever-evolving landscape of journalism and media, standing out from the crowd requires more than just talent. It demands specialized knowledge, a unique perspective, and the resources to pursue impactful storytelling. [...]
Unlocking Journalistic Potential: A Guide to Niche Fellowships and Funding Your Passion
Beyond the Headlines: Finding Your Perfect Journalism Fellowship The world of journalism is constantly evolving, demanding specialized skills and a commitment to in-depth reporting. While many aspiring journalists dream of landing coveted positions at major news outlets, journalism fellowships offer [...]
Beyond Subscriptions: Innovative Funding Models Fueling Modern Journalism
The Evolving Landscape of Journalism Funding The media industry is in constant flux, and with it, the ways journalism is funded. Traditional models, reliant on advertising and print subscriptions, are no longer sufficient to sustain robust news organizations. This necessitates [...]
Boston Dynamics’ Atlas: From Backflips to Factory Floors – How Hyundai Cracked the Humanoid Robot Code
The Robot Revolution is Here: Atlas Enters Mass Production For years, humanoid robots have captivated our imaginations, relegated to the realm of science fiction and impressive but ultimately impractical demonstrations. But the landscape is shifting dramatically. Boston Dynamics, long the [...]
Hublot Unico: Misunderstood or Masterpiece? A Watchmaker’s In-Depth Review
Hublot. The name alone often evokes strong reactions within the watch community. Some admire its bold designs and innovative use of materials, while others criticize its perceived lack of heritage and focus on marketing. But what's the reality? Is Hublot [...]
Unlock Your Potential: A Guide to Journalism Scholarships and Fellowships
Crafting Your Future: Journalism Scholarships and Fellowships Await The world of journalism is dynamic and ever-evolving, demanding skilled storytellers, critical thinkers, and ethical reporters. But the path to becoming a successful journalist can be financially challenging. Fortunately, numerous scholarships and [...]
The Evolving Landscape of Media: Navigating Tech, Trends, and Transformation
The Media Industry's Digital Metamorphosis The media landscape is in constant flux, driven by rapid technological advancements and shifting consumer behaviors. Staying ahead requires a deep understanding of emerging trends and a willingness to embrace innovation. From artificial intelligence to [...]
Navigating the Ethical Minefield: AI Content Authenticity and the Human Touch
Beyond the Hype: AI as a Creative Partner Artificial intelligence is rapidly transforming how we create content, from crafting marketing copy to composing musical scores. But instead of viewing AI as a replacement for human creativity, we should explore its [...]
Navigating the Murky Waters: AI Content Authenticity in the Age of Synthetic Media
Beyond Human: The Blurring Lines of Creation We're entering an era where the digital world is increasingly populated by content not crafted by human hands, but by artificial intelligence. This AI-generated material spans everything from personalized marketing emails to surprisingly [...]
HigherEdLeadership: Cultivating Innovation and Shaping Future Leaders
Navigating the Future: Leadership in Higher Education The world of higher education is transforming rapidly, presenting academic leaders with a complex set of hurdles. From integrating cutting-edge technologies to championing inclusivity and equal access, the expectations are higher than ever. [...]
Navigating the Future of HigherEdLeadership: Profiles and Pathways
Higher Education Leadership: A Shifting Paradigm The realm of higher education is undergoing a profound transformation, grappling with technological advancements, evolving student populations, and heightened expectations for demonstrable outcomes. Leading effectively in this environment demands more than just fiscal management [...]
Beyond the Scale: Recognizing Real Progress in Your Journey
The Scale's Deception: Why Numbers Aren't the Definitive Story We're often obsessed with metrics. When it comes to well-being, that metric is often the number displayed on our scales. But what if that number is a poor representation of actual [...]
Ethical AI Marketing: Building Trust and Authenticity in the Age of Automation
The Dawn of Responsible AI in Marketing Artificial Intelligence is transforming marketing, offering unprecedented opportunities for personalized customer journeys, efficient workflows, and data-driven insights. However, this technological leap necessitates a strong ethical framework. Marketers must proactively address concerns surrounding transparency, [...]
Unlocking Hyper-Personalization: Advanced AI Marketing Strategies for 2024
The Dawn of Individualized Marketing: AI's Next Frontier The marketing landscape is undergoing a profound shift. While traditional segmentation strategies group customers into broad categories, artificial intelligence is enabling a move towards true individualization. This isn't just about personalized emails; [...]
Leadership Styles: Shaping the Future Through Academic Excellence and Visionary Guidance
Leadership's Lasting Influence on University Life Leadership isn't just a theoretical idea; it's the engine that powers an organization forward. Within the distinct world of higher education, strong leadership is absolutely essential. University leaders are key in forming the minds [...]
Beyond the Textbook: Leadership Styles Shaping University Campuses
The Unseen Architects: Leadership Beyond Traditional Models Leadership extends far beyond corporate boardrooms, pulsating within the dynamic environment of university campuses. Management theories outline diverse leadership styles, but their practical implementation within academic institutions reveals fascinating complexities. Examining how these [...]
Beyond the Podium: Unveiling the Human Stories of University Leaders
We recognize them on stage, delivering commencement addresses or publicizing landmark discoveries. But what about the people guiding our universities? This piece goes beyond titles and degrees to uncover the personal narratives of influential higher education leaders. Discover their unique [...]
Beyond the Lecture Hall: Unveiling the Visionaries Steering University Education
Illuminating the Path: Profiles of Influential University Leaders Universities pulse with life beyond classrooms and textbooks, fueled by the dedication and foresight of their leaders. From chancellors to student representatives, these individuals sculpt the academic environment and ignite potential in [...]
Anthropic Surpasses OpenAI in Annualized Revenue: A Deep Dive into AI’s Evolving Landscape
The AI Revenue Race: Anthropic Takes the Lead The artificial intelligence landscape is shifting, and the latest developments signal a significant change in the competitive dynamics. Anthropic, a leading AI safety and research company, has reportedly surpassed OpenAI in annualized [...]
AI Revolution: China’s MiniMax Challenges OpenAI with Self-Improving Model
The Rise of Autonomous AI: A New Era Begins The landscape of artificial intelligence is undergoing a seismic shift, moving beyond simple prompt-based tools toward sophisticated systems capable of planning, reasoning, and executing complex tasks with minimal human intervention. Several [...]
AI-Powered Personalization: Transforming Employee Experiences in the Modern Workplace
The Dawn of the Individualized Workplace: How AI is Leading the Charge For years, Artificial Intelligence (AI) has been touted for its ability to streamline processes and automate tasks. However, its true potential lies in its capacity to personalize the [...]
Beyond Algorithms: The Ethical Frontier of AI-Powered Personalization
Beyond Targeted Ads: The New Era of AI-Driven Experiences We've moved beyond simple targeted advertising. Artificial intelligence is now capable of crafting hyper-personalized experiences that anticipate our needs and desires, seemingly before we even realize them ourselves. This level of [...]
Beyond Grants: Unconventional Funding Avenues for Modern Journalism
Navigating the Evolving Landscape of Journalism Funding The media landscape is in constant flux, demanding innovative approaches to sustain quality journalism. While traditional grants remain a vital source, relying solely on them can be limiting. This article explores alternative and [...]
Unlocking Opportunities: A Guide to Niche Media Fellowships
Beyond the Headlines: Finding Your Niche in Media Fellowships In the competitive world of journalism and media, fellowships offer invaluable opportunities for growth, skill development, and networking. While many aspiring media professionals are familiar with general media fellowships, exploring niche [...]
Unlocking Journalistic Potential: A Deep Dive into Niche Fellowships
Beyond the Headlines: Finding Your Journalistic Niche Through Fellowships In the ever-evolving landscape of journalism, specialization has become increasingly valuable. While traditional fellowships offer broad experiences, niche fellowships provide targeted opportunities to hone your skills and delve into specific areas [...]
Beyond Subscriptions: Innovative Funding Models for Journalism in the Digital Age
The Evolving Landscape of Journalism Funding The media landscape is in constant flux, and with it, the ways journalism is funded are also transforming. Traditional models, heavily reliant on advertising revenue and print subscriptions, are facing unprecedented challenges. This necessitates [...]
Unlock Your Potential: A Comprehensive Guide to Journalism Scholarships and Fellowships
Funding Your Future in Journalism The world of journalism is constantly evolving, demanding skilled and passionate individuals to report on critical issues and shape public discourse. However, pursuing a journalism education can be financially challenging. Fortunately, numerous scholarships and fellowships [...]
Revolutionizing Media: Emerging Technologies Shaping the Future
The Media Landscape Transformed: Navigating the New Technological Frontier The media industry, a dynamic and ever-evolving ecosystem, stands at the cusp of a technological revolution. From artificial intelligence (AI) to cloud computing, emerging technologies are reshaping content creation, distribution, and [...]
The AI Convergence: Why Every AI Product Seems the Same
The Great AI Homogenization Have you noticed a certain sameness creeping into the world of AI products? It's not just your imagination. A powerful convergence is underway, shaping the future of artificial intelligence and leading to a landscape where many [...]
Monkart Episode 52: A Deep Dive into the Animated World of Monster Battles
Monkart Episode 52: Unpacking the Latest Chapter Episode 52 of Monkart has arrived, continuing the saga of transforming Monkart vehicles and their epic battles. Available on MonkartTV across various language channels, including Korean, Chinese, and Spanish, this episode promises to [...]
The Rise of Artificial Humans: Robots Evolving Faster Than Ever
Robotics Revolution: Are Artificial Humans Finally Here? The field of robotics is experiencing an unprecedented surge in innovation, blurring the lines between science fiction and reality. Recent advancements are not just about building robots; they're about creating artificial humans with [...]
AI-Powered Personalization: Crafting Hyper-Relevant Customer Experiences
Beyond Segmentation: AI's Personalized Touch Imagine a world where every advertisement, every product suggestion, every customer service interaction feels tailor-made just for you. This isn't a futuristic fantasy; it's the reality being shaped by artificial intelligence (AI) in the realm [...]
Unlocking Hyper-Personalization: Advanced AI Marketing Strategies
From Reactive to Proactive: The AI-Powered Marketing Shift We've moved beyond the era of simply automating tasks with Artificial Intelligence (AI). Today, AI empowers marketers to create autonomous campaigns that learn, adapt, and optimize in real-time. Instead of just responding [...]
Leadership Styles: Cultivating Innovation and Collaboration in Academia
Reimagining Leadership in Higher Education Leadership isn't a uniform concept. Within the intricate world of academia, impactful leadership demands flexibility, foresight, and a nuanced grasp of the specific hurdles and possibilities. This article examines diverse leadership philosophies and highlights individuals [...]
Beyond the Textbook: Unveiling Leadership Styles in Academia’s Ivory Towers
Charting the Course: Leadership in the Academic Realm Leadership within universities presents distinct challenges. It demands not just intellectual prowess and specialized knowledge, but also the capacity to galvanize, encourage, and direct a varied group of academics, scientists, and learners. [...]
Beyond the Podium: Unveiling the Leadership Styles of University Titans
Leading a university is more than just managing budgets and soliciting donations. It's about cultivating an environment where intellectual exploration flourishes and shaping the leaders of tomorrow. This article examines the unique leadership approaches of those guiding prominent universities, revealing [...]
Inspiring Minds: Profiles of Visionary Leaders Shaping Higher Education
Leading the Charge: A Look at University Presidents and Provosts Universities are dynamic hubs of learning and discovery, powered by the vision and commitment of extraordinary leaders. From the president's office to cutting-edge research facilities, dedicated individuals are instrumental in [...]
Unlocking AI’s Potential: Beyond 30-Second Soundbites
AI: More Than Just a Buzzword Artificial intelligence. It's a term thrown around constantly, often with a sense of awe or apprehension. But what's really happening beneath the surface of these algorithms and neural networks? While a 30-second video might [...]
Monkart Episode 52: A Deep Dive and Animation Industry Trends
Exploring the Thrills of Monkart Episode 52 Monkart's unique blend of dynamic animation, monster combat, and gripping narratives has resonated with viewers globally. Episode 52, accessible on MonkartTV's Korean, Chinese, and Spanish platforms, continues this captivating saga. While experiencing the [...]
Monkart Episode 52: A Deep Dive into the Animated World of Monster Transformation
Unveiling the Excitement of Monkart Episode 52 Monkart, the animated series that blends monster battles with thrilling transformations, continues to captivate audiences worldwide. Episode 52 delivers another exciting chapter in the ongoing saga. This article provides a comprehensive summary and [...]
Revolutionizing Storytelling: How AI and Emerging Technologies are Transforming Media
The Dawn of a New Media Landscape The media industry stands on the cusp of a technological revolution, driven by advancements in artificial intelligence (AI) and other emerging technologies. These innovations are not merely incremental improvements; they represent a fundamental [...]
Beyond Algorithms: The Human Side of AI-Powered Personalization
Beyond the Algorithm: The Heart of Personalized AI We've moved past the days of AI personalization being a futuristic concept; it's now an expected standard. Users crave experiences tailored precisely to their individual needs and desires. However, the relentless pursuit [...]
Unlock the Power of AI: Revolutionizing Personalization Across Industries
The Rise of the Individual: AI's Role in Personalized Engagement We've moved past the era of one-size-fits-all. Today's consumers demand experiences that resonate with their unique needs and preferences. Artificial intelligence (AI) has emerged as the key enabler of this [...]
Unlock Watchmaking Wonders: Top 10 Affordable Complications Under $500
Beyond the Basics: Exploring Affordable Watch Complications For watch enthusiasts, the allure of a timepiece often lies in its complications – those ingenious features beyond simply telling the time. Traditionally, complications have been associated with high-end watchmaking, commanding hefty price [...]
AI’s Transformative Power: Reshaping the Media Landscape in 2024 and Beyond
The AI Revolution: A New Dawn for Media The media industry stands on the cusp of a profound transformation, driven by the relentless advancement of artificial intelligence (AI). From content creation to distribution and consumption, AI is not just streamlining [...]
Unlocking Journalistic Potential: A Guide to Niche Funding and Resources
Beyond the Headlines: Finding Specialized Journalism Funding In an era of rapidly evolving media landscapes, securing funding for journalistic endeavors has become increasingly crucial. While general grants and fellowships offer broad support, exploring niche funding opportunities tailored to specific areas [...]
Unlock Your Potential: A Guide to Niche Media Fellowships
Beyond the Headlines: Finding Your Niche in Media Fellowships In the ever-evolving landscape of journalism and media, the pursuit of deeper knowledge and specialized skills is more critical than ever. While general media fellowships offer invaluable experience, exploring niche fellowships [...]
Unlocking Journalistic Potential: A Guide to Fellowships for Specialized Reporting
Beyond the Byline: Fellowships as Launchpads for Niche Journalism In the ever-evolving media landscape, specialization is increasingly valuable. While general reporting provides a broad foundation, diving deep into a specific subject matter can elevate a journalist's career, impact, and expertise. [...]
Beyond Subscriptions: Exploring Innovative Journalism Funding Models
The Evolving Landscape of Journalism Funding The media landscape is in constant flux, and with it, the traditional funding models that have sustained journalism for decades are being challenged. While subscriptions and advertising remain important revenue streams, relying solely on [...]
Claude Mythos: The AI Model That’s Too Dangerous to Unleash
The Dawn of Cyber Offense: Anthropic's Mythos and the Shifting Security Landscape Imagine an AI so potent in cyber offense that its widespread release is deemed "reckless." This isn't science fiction; it's the reality of Anthropic's Claude Mythos Preview, a [...]
Unlock Your Potential: A Guide to Journalism Scholarships and Fellowships
Fueling the Future of Journalism: Scholarships and Fellowships Await Aspiring journalists often face a significant hurdle: funding their education and gaining invaluable experience. Fortunately, numerous scholarships and fellowships exist to support these future storytellers. These opportunities not only alleviate financial [...]
Beyond the Podium: Unveiling the Human Stories of University Leaders
Beyond the Office Door: University Leaders Unmasked We often see universities as sprawling campuses, defined by their academic rigor and groundbreaking studies. But within these institutions are people – leaders steering the ship, encouraging new ideas, and igniting passion in [...]
Beyond the Ivory Tower: Illuminating the Leadership of Academia’s Finest
The Architects of Tomorrow's Universities While often seen as keepers of the past, universities are vibrant communities guided by forward-thinking leaders. From presidents to student representatives, these individuals steer their institutions through evolving landscapes. This article spotlights some of the [...]
Leadership Styles in Academia: Shaping the Future of Higher Education
Academic Leadership: A Shifting Paradigm The nature of leadership within universities is changing dramatically. Traditional top-down structures are giving way to more dynamic and collaborative models. Today, academic leadership requires adaptability, teamwork, a strong understanding of diverse perspectives, and a [...]
Decoding Leadership: Exploring Diverse Styles and Impactful University Leaders
Understanding the Landscape of Leadership Approaches Leadership is multifaceted, not a rigid formula. True leadership prowess lies in recognizing and skillfully employing diverse strategies, each possessing unique advantages and potential drawbacks. Whether leading a close-knit group or a sprawling institution, [...]
Stop Chasing AI Tools: Build Your Own Productivity System
The Allure and Illusion of AI Productivity Tools Are you caught in a never-ending cycle of downloading, trying, and abandoning the newest AI-powered productivity apps? You're not alone. The promise of instant efficiency from tools like Bard or alternative AI [...]
Revolutionizing Next.js Development: 5 AI Coding Practices for 2024
Reimagining Next.js Development with AI The world of web development is rapidly changing, and AI is leading the charge. For Next.js developers, adopting AI-driven coding isn't just about keeping up with trends; it's about unlocking unprecedented efficiency, fostering creativity, and [...]
The AI Revolution: Goal-Driven Agents and the Future of Innovation
The Rise of Goal-Driven AI Agents The world of artificial intelligence is rapidly transforming. We're moving beyond simple prompt-based interactions towards sophisticated, goal-oriented systems. Recent advancements from companies like Google, OpenAI, Anthropic, and Z.ai exemplify this shift, sparking both excitement [...]
Ethical AI Marketing: Building Trust and Transparency
From Automation to Authenticity: Why Ethical AI is Marketing's New Frontier Artificial intelligence is transforming marketing, promising unprecedented automation and personalization. But in the rush to embrace these advancements, a critical question emerges: Are we sacrificing ethics at the altar [...]
Unlocking Growth: Best Practices for AI-Powered Marketing
The Marketing Landscape Transformed: Welcome to the Age of AI Forget crystal balls – artificial intelligence is the new oracle for marketers. It's no longer a futuristic fantasy, but a tangible force reshaping how we understand and engage with customers. [...]
Revolutionizing Storytelling: The Impact of Emerging Technologies on Media
The Media Landscape Transformed: A New Era of Storytelling The media industry stands on the precipice of a profound transformation, driven by the relentless march of emerging technologies. From personalized content experiences to the fight against disinformation, these advancements are [...]
Beyond the Byline: Media Fellowships as Launchpads for Innovation and Impact
Unlocking Untapped Potential: Media Fellowships as Catalysts In the ever-evolving landscape of media, standing out requires more than just talent and hard work. It demands a commitment to innovation, a passion for impactful storytelling, and a willingness to push boundaries. [...]
Unlocking Journalistic Potential: A Deep Dive into Niche Fellowships
Beyond the Headlines: Finding Your Journalistic Niche Through Fellowships Journalism, in its broadest sense, is about informing the public. But the media landscape is vast, and the most impactful reporting often comes from those who delve deep into specific areas. [...]
Beyond Subscriptions: Novel Funding Models Fueling Journalistic Innovation
The Evolving Landscape of Journalism Funding For years, the journalism industry has grappled with a shifting financial foundation. The traditional advertising model, once the bedrock of news organizations, has eroded under the pressure of digital platforms and changing consumer habits. [...]
Unlock Your Potential: A Guide to Journalism Scholarships and Fellowships
Fueling the Future of Journalism: Scholarships and Fellowships The world of journalism is constantly evolving, demanding innovative storytellers and dedicated reporters. However, pursuing a career in this field can be financially challenging. Fortunately, numerous scholarships and fellowships exist to support [...]
Inspiring Minds: Profiles of Transformative Leaders Shaping University Education
Beyond the Lecture Hall: The Human Side of University Leadership Universities, often perceived as monolithic entities, are in reality shaped by passionate individuals. These leaders drive innovation, cultivate potential, and equip students for the complexities ahead. This article delves into [...]
University Leadership: Profiles of Visionaries Shaping Higher Education
The Architects of Academia: Profiles in University Leadership Universities thrive as centers of learning, propelled by the dedication and foresight of remarkable individuals. From chief academic officers to student advocates, these leaders tackle multifaceted challenges and foster advancement. This piece [...]
Decoding the Microprocessor: A Deep Dive into LogicWorks LAB4
Unveiling the Inner Workings of a Microprocessor The microprocessor, the brain of modern computing, often seems like an impenetrable black box. But beneath the surface lies a fascinating world of logic gates, registers, and control signals working in perfect harmony. [...]
Unlocking Journalistic Potential: Funding Opportunities Beyond the Traditional Grant
Beyond the Grant: Navigating the Landscape of Journalism Funding In an era defined by rapid technological advancements and evolving media consumption habits, the role of journalism remains critical. However, securing funding for impactful reporting can be a significant hurdle. While [...]
OpenAI’s Grand Strategy: Shaping the Future of AGI Before It Shapes Us
OpenAI's Bold Blueprint for the Age of Superintelligence In a series of rapid-fire developments, OpenAI is not just building artificial general intelligence (AGI); it's actively shaping the world it will inhabit. From outlining industrial policy for the intelligence age to [...]
The Evolving Landscape of Media: Navigating AI, Consumption Habits, and Digital Freedoms
The Media Revolution: A Convergence of Technology and Shifting Habits The media industry is in constant flux, driven by rapid technological advancements and evolving consumer behaviors. From artificial intelligence transforming content creation to shifting preferences in how we consume media, [...]
Navigating the Ever-Changing Landscape of Social Media Trends
Understanding the Dynamic World of Social MediaSocial media has become an integral part of modern life, influencing how we communicate, consume information, and conduct business. The landscape is constantly evolving, with new platforms, features, and user behaviors emerging regularly. Staying [...]
Decoding Watch Finishes: PVD vs. Solid Gold
The Golden Question: Is Your Watch Truly Gold? A gold watch is a statement. But how can you be sure you're getting the real deal and not just a clever imitation? The world of watch finishes can be confusing, especially [...]
Unlocking Opportunities: A Deep Dive into Niche Media Fellowships
Beyond the Headlines: Discovering Specialized Media Fellowships The world of media fellowships extends far beyond the general calls for journalists. While those are undoubtedly valuable, a wealth of opportunities lies within specialized, niche programs designed to nurture expertise in specific [...]
Unearthing Hidden Gems: Niche Journalism Fellowships You Haven’t Considered
Beyond the Headlines: Exploring Unconventional Journalism Fellowships The world of journalism is constantly evolving, demanding adaptability and specialized knowledge. While prestigious fellowships often dominate the spotlight, a wealth of niche opportunities exist, tailored to specific interests and career goals. These [...]
PVD vs. Real Gold Watches: Identifying the Difference and Future Trends in Watchmaking
Gold-Tone or Pure Gold: Dissecting Watch Materials Gold watches exude timeless elegance, but what appears to be gold isn't always what it seems. Many watches employ PVD (Physical Vapor Deposition) finishes to emulate the luxurious look of gold, offering a [...]
Beyond Subscriptions: Innovative Funding Models Fueling Modern Journalism
The Evolving Landscape of Journalism Funding For decades, journalism relied heavily on advertising revenue and subscription models. However, the digital age has disrupted these traditional streams, forcing news organizations to explore new and innovative ways to sustain their operations and [...]
Abacus CoWork: The AI Desktop Tool That Could Revolutionize Workflows
Beyond Chatbots: A New Era of AI Utility The AI landscape is rapidly evolving, moving beyond simple chatbot interactions towards tools that can truly transform how we work. Abacus has just released CoWork, an AI desktop application that's generating significant [...]
PVD vs. Gold: How to Tell the Difference in Your Watch
A gold watch exudes luxury and timeless appeal. But not all that glitters is gold. With advancements in coating technologies, it can be challenging to distinguish between a genuine gold watch and one finished with PVD (Physical Vapor Deposition). This [...]
AI Revolutionizes Kafka Management: Confluent Cloud and Claude Desktop Integration
The Dawn of AI-Powered Kafka Management The world of data streaming is rapidly evolving, and at the forefront of this transformation is the integration of Artificial Intelligence (AI) with established platforms like Apache Kafka. A recent breakthrough showcases the powerful [...]
Unlock Your Potential: A Guide to Journalism Scholarships and Fellowships
Forging Your Path in Journalism: Funding the Future of News The world of journalism is constantly evolving, demanding skilled and passionate individuals to inform the public and hold power accountable. However, the path to becoming a journalist can be financially [...]
Revolutionizing Media: How AI and Emerging Technologies are Shaping the Future of Content
The Media Landscape Transformed: A New Era of Innovation The media industry is undergoing a seismic shift, driven by rapid advancements in artificial intelligence (AI) and other emerging technologies. From content creation and distribution to audience engagement and monetization, these [...]
Journalism Scholarships: Funding Your Future in Media
Introduction A career in journalism offers a unique opportunity to inform, educate, and influence public opinion. However, pursuing a journalism degree can be financially challenging. Fortunately, numerous scholarships are available to help aspiring journalists fund their education. This article provides [...]
List of Successful Applicants for Media Training on Standards & Metrology Reporting (2026)
The Uganda National Bureau of Standards (UNBS) in partnership with TradeMark Africa (TMA), has released the final list of successful applicants for the 2026 Media Training on Standards and Metrology Reporting. The specialized capacity-building programme will bring together selected journalists, [...]
Emerging Technologies in the Media Industry: Navigating the Future
The Media Industry at a CrossroadsThe media industry is undergoing a dramatic transformation, driven by rapid technological advancements and shifting consumer preferences. As traditional media formats struggle to keep pace, digital platforms are emerging as the new frontier [...]
Exploring Journalism Funding Opportunities: Unlocking the Future of Media
The Changing Landscape of Journalism FundingIn an era where traditional media faces unprecedented challenges, journalism funding opportunities have become more critical than ever. The landscape is shifting, driven by technological advancements and changing consumer behaviors. As newsrooms shrink and independent [...]
Exploring Media Fellowships: A Gateway to Career Advancement
The Unique Landscape of Media FellowshipsIn an era where storytelling is paramount, media fellowships have emerged as critical avenues for aspiring journalists, communicators, and content creators. These programs not only provide invaluable experience but also foster a deeper understanding of [...]
Exploring the World of Journalism Fellowships: Opportunities for Aspiring Journalists
The Pathway to Excellence: Journalism FellowshipsIn an era where the landscape of journalism is continuously evolving, journalism fellowships have emerged as a beacon of opportunity for aspiring journalists. These fellowships not only enhance one's skills but also open [...]
The Future of Journalism Funding: Navigating New Financial Landscapes
The Changing Landscape of Journalism FundingIn an era where the digital age continuously reshapes the world of journalism, funding sources are evolving at an unprecedented pace. Traditional revenue streams, such as print advertising and subscription models, are being challenged by [...]
Unlocking Opportunities: A Comprehensive Guide to Journalism Scholarships and Fellowships
Mapping the Path to Journalism SuccessIn an age where the media landscape is evolving at a breakneck pace, aspiring journalists find themselves at a crossroads. The challenge is not just about honing their craft but also navigating the [...]
Navigating the New Frontier: Leaders Managing Humans and AI
The New Age of LeadershipIn an era marked by rapid technological advancement, the role of leadership is evolving dramatically. Today, leaders are not just managing teams of humans; they are now tasked with orchestrating the complex interactions between [...]
Unleashing the Power of Automation: 100% Automated Blogging with AI Agents in n8n
Revolutionizing Blogging with AutomationIn an era where content is king, the demands on bloggers have never been higher. The quest for efficiency and creativity often leads to a daunting workload. Enter n8n, a groundbreaking tool designed to automate [...]
The Transformative Impact of AI in the Media Industry
The Transformative Impact of AI in the Media IndustryIn an era defined by rapid technological advancement, the media industry stands at the forefront of transformation. The integration of Artificial Intelligence (AI) is not merely a trend; it is [...]
Unlocking the Future: Journalism Funding Opportunities for Aspiring Reporters
The Evolving Landscape of Journalism FundingIn a world where journalism is increasingly threatened by budget cuts and the rise of misinformation, funding opportunities for budding journalists have never been more vital. For many aspiring reporters, the challenge lies [...]
Media Fellowships: Unlocking Opportunities for Aspiring Journalists
Introduction to Media FellowshipsIn an era where information is as valuable as currency, the importance of skilled journalists cannot be overstated. Media fellowships serve as a bridge for aspiring journalists, offering them opportunities to hone their skills, gain [...]
Unlocking Opportunities: The Transformative Power of Journalism Fellowships
The Rising Importance of Journalism FellowshipsIn an era where the landscape of journalism is rapidly evolving, journalism fellowships have emerged as vital stepping stones for aspiring reporters and seasoned professionals alike. These programs offer unique opportunities to enhance [...]
Innovative Funding Models Reshaping Journalism in the Digital Age
The Evolving Landscape of Journalism FundingIn an era where traditional revenue streams for journalism are dwindling, the quest for sustainable funding has become a critical issue for news organizations worldwide. As advertising budgets shift to digital giants, the [...]
Unlocking Opportunities: A Comprehensive Guide to Journalism Scholarships and Fellowships
The Path to Becoming a JournalistIn an era where information reigns supreme, the role of journalists has never been more crucial. Yet, aspiring journalists often face the daunting challenge of financing their education. Fortunately, a plethora of scholarships [...]
More AI Datacenter Community Commitments: A New Era of Responsibility
OpenAI's Stargate Community CommitmentsIn an era where rapid advancements in artificial intelligence are reshaping our world, OpenAI has stepped forward with the Stargate Community commitments, a series of initiatives designed to minimize the environmental impacts of datacenters. Recognizing [...]
Ramadan Trends 2026: A Viral Celebration of Faith and Community
The Buzz Around Ramadan: A Cultural PhenomenonAs the crescent moon reappears, signaling the start of Ramadan, a wave of excitement washes over the Muslim community worldwide. In 2026, this anticipation has reached new heights, particularly with the captivating [...]
The Evolution of AI in the Media Industry: Trends, Technologies, and Future Outlooks
The Digital Transformation of Media: AI at the ForefrontAs we step into a new era of digital media, artificial intelligence (AI) has become the linchpin of innovation and efficiency. The media industry, encompassing everything from news outlets to [...]
Exploring the Landscape of Journalism Funding Opportunities
Unveiling the Hidden Treasures in Journalism FundingIn an era where the integrity of journalism faces unprecedented challenges, securing adequate funding has become a pressing concern for many aspiring and established journalists alike. Innovative funding opportunities are emerging, offering a lifeline [...]
Unlocking Opportunities: The Transformative Power of Media Fellowships
The World of Media FellowshipsMedia fellowships are more than just prestigious accolades; they are gateways to invaluable experiences that can shape the careers of aspiring journalists and media professionals. These programs offer an immersive environment where participants can [...]
Unlocking Opportunities: The Transformative Power of Journalism Fellowships
A New Era of Journalism FellowshipsIn an age where the media landscape is constantly evolving, journalism fellowships have emerged as a beacon of hope for aspiring journalists. These programs provide invaluable opportunities for professional development, networking, and hands-on experience. They [...]
Innovative Paths in Journalism Funding: Navigating New Financial Landscapes
The Evolving Landscape of Journalism FundingIn an era where traditional revenue streams for journalism are rapidly diminishing, the need for innovative funding solutions has never been more pressing. As readership migrates to digital platforms, the financial sustainability of [...]
Unlocking Opportunities: A Comprehensive Guide to Journalism Scholarships and Fellowships
Fueling Ambitions: The World of Journalism ScholarshipsIn an age where the spread of information is instantaneous and the demand for credible reporting is higher than ever, aspiring journalists must navigate not only the complexities of their craft but also the [...]
Google Says No Ads Planned for Gemini: Insights from Davos
Understanding Google's Position on Ads in GeminiIn a world where monetization strategies are evolving rapidly, Google has made headlines with its recent announcement regarding its AI model, Gemini. During discussions at the World Economic Forum in Davos, the [...]
Unlocking the Power of Mathematics in Artificial Intelligence
The Foundation of AI: MathematicsIn the rapidly evolving world of technology, artificial intelligence (AI) stands as a beacon of innovation, poised to reshape our future. However, the backbone of AI isn't merely advanced coding or vast datasets; it [...]
The Evolution of AI in the Media Industry: Trends and Innovations
Transforming the Landscape: AI's Role in Modern MediaAs the sun sets on the traditional media landscape, a new dawn breaks, illuminated by the advancements in artificial intelligence (AI). This technological revolution is not merely a trend but a [...]
Exploring Journalism Funding Opportunities: A Path to Sustainable Reporting
Unlocking the Future of JournalismIn an era where traditional media faces unprecedented challenges, the quest for funding in journalism has never been more critical. Journalists and media organizations are increasingly seeking innovative financial solutions to support independent reporting [...]
Unveiling Media Fellowships: A Pathway to Transformative Storytelling
The Growing Influence of Media FellowshipsIn the rapidly evolving landscape of journalism, media fellowships have emerged as a crucial stepping stone for aspiring storytellers. These programs not only offer financial support but also provide invaluable training and networking opportunities that [...]
Navigating the World of Journalism Fellowships: Opportunities and Insights
Unlocking Opportunities: The Power of Journalism FellowshipsIn the ever-evolving landscape of journalism, fellowships serve as a pivotal gateway for aspiring reporters and seasoned professionals alike. These programs not only provide invaluable experience but also offer financial support, mentorship, [...]
Exploring Innovative Paths to Journalism Funding
The Funding Landscape for Journalism: An Evolving NarrativeIn an era where newsrooms are closing and investigative reporting faces unprecedented challenges, the funding of journalism has emerged as a pivotal topic. With traditional revenue streams dwindling, innovative strategies are [...]
Unlocking Opportunities: A Comprehensive Guide to Journalism Scholarships and Fellowships
The Power of Journalism ScholarshipsIn the ever-evolving world of journalism, the need for skilled storytellers has never been greater. As aspiring journalists step into this vibrant field, the financial burden of tuition can often feel insurmountable. Fortunately, a [...]
AGI Timelines Shift Forward: Navigating the Future of AI
Shifting Paradigms in AI DevelopmentThe recent discussions at Davos have ignited a firestorm of debate among AI experts, marking a pivotal moment in the trajectory of artificial intelligence (AI) development. As the world watches closely, the conversation surrounding artificial general [...]
The Evolution of AI in the Media Industry: Trends and Technologies Shaping 2024
Revolutionizing Media: The Role of AIAs the sun rises on 2024, the media industry stands at a pivotal juncture, embracing transformative technologies that promise to reshape its landscape. From artificial intelligence (AI) to cloud computing, innovations are not [...]
Exploring Journalism Funding Opportunities: A Path to Sustainable Reporting
Understanding the Landscape of Journalism FundingIn an age where the media landscape is continually shifting, journalists are increasingly seeking innovative funding opportunities to sustain their work. The rise of digital media, coupled with declining traditional revenue streams, has [...]
Unlocking Opportunities: A Deep Dive into Media Fellowships
Understanding Media FellowshipsIn a world where the digital landscape is constantly evolving, media fellowships have emerged as vital avenues for aspiring journalists, storytellers, and communicators to hone their skills and expand their professional networks. These fellowships provide not only financial [...]
The Pathways of Journalism Fellowships: A Comprehensive Guide
Unveiling Journalism FellowshipsIn the evolving landscape of media, journalism fellowships serve as a vital bridge for aspiring and established journalists alike. These programs not only provide funding and training but also offer invaluable networking opportunities, mentorship, and unique [...]
Navigating the Future of Journalism Funding: Opportunities and Challenges
The Evolving Landscape of Journalism FundingIn an era where information is both abundant and valuable, the quest for effective journalism funding has become increasingly complex. Traditional revenue streams are drying up, leaving a void that aspiring journalists and [...]
Unlocking Opportunities: A Guide to Journalism Scholarships and Fellowships
Gateway to Success: Journalism Scholarships and FellowshipsIn a world where the truth is often overshadowed by sensationalism, aspiring journalists find themselves at a crossroads of opportunity and financial challenge. The pursuit of a journalism degree can be daunting, [...]
The Whole World Gets Claude-Pilled: Revolutionizing Coding and Automation
Unleashing the Power of AI: The Claude BreakoutIn the ever-evolving landscape of artificial intelligence, Anthropic has made waves with the launch of Claude, a multi-faceted tool designed to democratize coding and automation. Dubbed as a game-changer, Claude Code and Claude [...]
Navigating the Laptop Warranty Claim Process: A Comprehensive Guide
Understanding Laptop WarrantiesWhen purchasing a laptop, many consumers often overlook one crucial aspect: the warranty. A laptop warranty is a promise from the manufacturer that covers repairs or replacements for a certain period, typically ranging from one to three years [...]
Harnessing AI and Emerging Technologies in the Media Industry
The Convergence of AI and Media: A New EraIn an age where technology evolves at a breakneck speed, the media industry stands on the precipice of a revolutionary transformation. From artificial intelligence (AI) to cloud computing, media companies are increasingly [...]
Exploring Innovative Funding Opportunities for Journalists
The Landscape of Journalism FundingIn an era where traditional media is continually challenged by digital transformation, funding for journalism has evolved into a crucial subject. The financial sustainability of newsrooms, independent journalists, and media startups hinges on innovative [...]
Unlocking Opportunities: A Comprehensive Guide to Media Fellowships
What Are Media Fellowships?Media fellowships are specialized programs designed to support emerging journalists and media professionals in honing their craft while addressing critical social issues. These fellowships offer a unique blend of mentorship, hands-on training, and networking opportunities, enabling participants [...]
A Deep Dive into Journalism Fellowships: Unlocking Opportunities for Aspiring Journalists
Understanding Journalism FellowshipsIn the ever-evolving landscape of media, journalism fellowships have emerged as a pivotal stepping stone for aspiring journalists. These programs not only provide financial support but also enable emerging talents to gain invaluable experience, network with [...]
Navigating the Future of Journalism Funding: Innovations and Opportunities
The Evolving Landscape of Journalism FundingIn an age where the traditional revenue models of journalism are being rapidly disrupted, the quest for sustainable funding has never been more critical. With the rise of digital platforms and a changing [...]
Navigating the Landscape of Journalism Scholarships and Fellowships
The Path to Journalism: Opportunities AwaitIn a world where information flows faster than ever, aspiring journalists face unique challenges and exhilarating opportunities. The key to unlocking a successful career in journalism often lies in financial support through scholarships [...]
The Rise of AI Wearables: A Second Chance for Innovation
AI Wearables: A New Era of InnovationThe world of technology is constantly evolving, and at the forefront of this evolution is the burgeoning field of AI wearables. With recent advancements, we are witnessing a significant shift in the [...]
The Evolution of AI Technology in the Media Industry: Trends and Innovations
The Dawn of a New Era in Media TechnologyIn the rapidly evolving landscape of the media industry, artificial intelligence (AI) has emerged as a transformative force. From enhancing content creation to revolutionizing audience engagement, AI technologies are reshaping [...]
Exploring Innovative Funding Opportunities for Journalism
The Evolving Landscape of Journalism FundingIn an era where traditional media models are being challenged, journalism faces a critical turning point. The digital age has not only transformed how news is consumed but also how it is funded. [...]
Unlocking Opportunities: The Power of Media Fellowships
The Transformative Journey of Media FellowshipsIn the fast-evolving landscape of journalism and media, opportunities for growth and specialization are crucial. Media fellowships serve as a launchpad for aspiring journalists, offering them not just financial support but also invaluable [...]
Unlocking Opportunities: The Transformative Power of Journalism Fellowships
The Role of Journalism Fellowships in Modern MediaIn an era where the media landscape is constantly evolving, journalism fellowships have emerged as pivotal stepping stones for aspiring reporters and seasoned professionals alike. These fellowships not only provide financial [...]
Navigating the Future of Journalism Funding: Opportunities and Challenges
The Evolving Landscape of Journalism FundingAs the digital age transforms the media landscape, journalism funding has become a critical topic of discussion. With traditional revenue models faltering, journalists and media organizations are exploring innovative ways to finance their [...]
Unlocking Opportunities: A Comprehensive Guide to Journalism Scholarships and Fellowships
Navigating the Financial Landscape of Journalism EducationIn the ever-evolving world of journalism, aspiring reporters and media professionals often find themselves confronting a significant barrier: the financial burden of education. With tuition costs soaring and the job market becoming increasingly competitive, [...]
What Happens When AI Obliterates Your Business Model?
Unveiling the Impact of AI on Business ModelsThe rapid rise of artificial intelligence (AI) is not just a technological advancement; it is a seismic shift that is redefining traditional business paradigms. As AI-driven coding agents increasingly penetrate the [...]
Navigating the Future: How Emerging Technologies are Reshaping the Media Industry
Unleashing the Power of AI in MediaAs we traverse through the digital age, the media industry stands on the brink of a revolution, driven by cutting-edge technologies that are redefining how content is created, consumed, and monetized. Among [...]
Exploring Journalism Funding Opportunities: Unlocking Your Potential
Understanding the Landscape of Journalism FundingIn an age where the media landscape is undergoing rapid transformation, funding opportunities for journalism have become more crucial than ever. As traditional revenue streams dwindle, aspiring journalists and media organizations are seeking [...]
Unlocking Opportunities: The Transformative Power of Media Fellowships
Understanding Media FellowshipsIn an era where the media landscape is rapidly evolving, media fellowships have emerged as essential stepping stones for aspiring journalists, content creators, and communication professionals. These prestigious programs not only offer invaluable experience but also [...]
Navigating the World of Journalism Fellowships: Opportunities for Aspiring Reporters
The Launchpad for Tomorrow's JournalistsIn the fast-evolving landscape of journalism, fellowships serve as invaluable stepping stones for aspiring reporters. These programs not only hone your writing skills but also provide access to industry networks, mentorship, and real-world experience. [...]
The Future of Journalism Funding: Navigating New Avenues for Support
The Landscape of Journalism FundingIn an era where misinformation spreads like wildfire and public trust in media wanes, the financial backbone of journalism faces unprecedented challenges. As traditional revenue streams dry up, funding for journalism is evolving. From [...]
Navigating the World of Journalism Scholarships: A Comprehensive Guide
Unlocking Opportunities in JournalismIn a rapidly evolving media landscape, aspiring journalists are more than just storytellers; they are the architects of public discourse. The path to a successful journalism career can be laden with financial burdens, but there [...]
Harnessing AI for Health: Transforming Healthcare Delivery
Revolutionizing Health with AIThe advent of artificial intelligence (AI) is reshaping the landscape of healthcare, making it more accessible and efficient. With OpenAI's recent launch of ChatGPT Health, a dedicated encrypted workspace that connects medical records with wellness [...]
Navigating the Future: AI and Emerging Technologies in the Media Industry
The Dawn of AI in MediaAs the sun rises on the media landscape, artificial intelligence (AI) is emerging not just as a tool but as a transformative force. The media industry, ever-evolving and adapting, now finds itself at the intersection [...]
Unlocking Journalism: A Guide to Funding Opportunities in the Digital Age
Exploring New Frontiers in Journalism FundingAs the media landscape evolves, the need for innovative journalism has never been more pressing. Funding opportunities for journalists are abundant, yet often overlooked. The shifting dynamics of the industry demand that storytellers not only [...]
Unlocking Opportunities: The Impact of Media Fellowships on Aspiring Journalists
Discovering the World of Media FellowshipsIn the world of journalism, the path to success is often paved with experience, mentorship, and networking. Media fellowships offer aspiring journalists a unique opportunity to gain hands-on experience, develop their skills, and build valuable [...]
Navigating the Landscape of Journalism Fellowships: A Pathway to Professional Growth
The Transformative Power of Journalism FellowshipsIn an ever-evolving media landscape, journalism fellowships have emerged as a vital stepping stone for aspiring journalists. These programs offer an unparalleled opportunity for emerging professionals to hone their skills, build networks, and gain real-world [...]
Exploring Innovative Funding Models for Journalism in the Digital Age
The Evolving Landscape of Journalism FundingIn an era where traditional advertising revenues are dwindling and public trust in media is being challenged, journalism funding is rapidly evolving. The essential question arises: how can we sustain quality journalism while [...]
Navigating the Landscape of Journalism Scholarships: Opportunities for Aspiring Journalists
Unlocking Opportunities in JournalismIn a world where information flows at lightning speed, aspiring journalists are more than mere reporters; they are the architects of public discourse. Yet, the financial barriers to pursuing a degree in journalism can be daunting. Fortunately, [...]
The Rise of Claude Code: Revolutionizing AI Coding and Beyond
Unleashing the Power of AI: Why Claude Code Is Captivating the Tech WorldIn a world where technology is evolving at breakneck speed, the introduction of Claude Code and Opus 4.5 has ignited a fervor within the tech community. [...]
Essential Laptop Charger User Guide: Maximize Safety and Efficiency
Understanding the Components of Your Laptop ChargerThe laptop charger is one of the most crucial accessories for your device, yet it often goes overlooked. Many users plug in their chargers without a second thought, but understanding the components [...]
The Future of Media: Embracing AI and Emerging Technologies
Transforming the Media Landscape with AIThe media industry, once dominated by traditional practices and linear consumption, is undergoing a profound metamorphosis. With the integration of artificial intelligence (AI) and other emerging technologies, media companies are not just adapting; they are [...]
Unlocking Journalism Funding Opportunities: A Comprehensive Guide
The Changing Landscape of Journalism FundingIn the rapidly evolving world of journalism, funding remains a critical challenge for many aspiring journalists and established media outlets alike. As traditional revenue streams dwindle, innovative funding opportunities are emerging, allowing journalists to pursue [...]
Navigating the Landscape of Media Fellowships: A Comprehensive Guide
The Transformative Power of Media FellowshipsIn an era where the media landscape is rapidly evolving, media fellowships have emerged as pivotal opportunities for aspiring journalists and media professionals. These fellowships not only provide financial support but also offer [...]
Unlocking Opportunities: The Transformative Power of Journalism Fellowships
The Landscape of Journalism FellowshipsIn an era where information flows ceaselessly and the digital landscape is ever-evolving, journalism fellowships have emerged as pivotal opportunities for budding journalists and seasoned professionals alike. These fellowships not only provide financial support but also [...]
Navigating the Landscape of Journalism Scholarships and Fellowships
Unlocking Opportunities: Journalism Scholarships and FellowshipsIn a world where the pulse of news beats rapidly, aspiring journalists are constantly seeking ways to break into the industry. With the rising costs of education, scholarships and fellowships have become invaluable [...]
Innovative Funding Models for the Future of Journalism
The Shifting Landscape of Journalism FundingIn the rapidly evolving world of journalism, traditional funding models are increasingly being challenged. With the rise of digital media and the decline of print advertising revenue, journalists and media organizations are seeking innovative funding [...]
ChatGPT is Now a Browser: Revolutionizing Online Interaction with Atlas
Unleashing the Power of AI in Web BrowsingIn a groundbreaking move, OpenAI has unveiled Atlas, a revolutionary browser that integrates artificial intelligence to redefine how we interact with the web. Imagine a tool that not only navigates the [...]
Exploring the Latest in Technology Trends: A Deep Dive into Innovation
Unveiling the Future: Technology Trends You Can't IgnoreIn an age dominated by rapid advancements, technology shapes our lives in unprecedented ways. The video titled Live Highlight encapsulates this dynamic world, offering insights and updates on emerging trends that [...]
Harnessing AI and Emerging Technologies in the Media Industry
Revolutionizing Media through AI TechnologyThe media industry is undergoing a profound transformation propelled by artificial intelligence (AI) and emerging technologies. With the rapid advancement of digital capabilities, media companies are now better equipped to deliver content that resonates with audiences, [...]
The Future of Journalism Funding: Navigating Challenges and Opportunities
The Landscape of Journalism FundingIn an era where the relevance of traditional media is continually being challenged, the funding of journalism has taken center stage. As public trust in media dwindles, innovative funding solutions are becoming pivotal for [...]
Navigating the Landscape of Journalism Scholarships and Fellowships
Unlocking Opportunities: Journalism Scholarships and FellowshipsThe journey of a budding journalist is often fraught with challenges, particularly when it comes to financing education. Fortunately, a wealth of scholarships and fellowships exists to support aspiring journalists in their quest [...]
Navigating the New Era of Media: The Transformative Role of AI and Emerging Technologies
The Future of Media: A Technological RevolutionAs we venture deeper into the 21st century, the media landscape is undergoing a radical transformation. The fusion of artificial intelligence (AI) and emerging technologies is not just reshaping how content is [...]
Exploring Innovative Solutions for Journalism Funding
The State of Journalism Funding: A Complex LandscapeAs the digital age reshapes the media landscape, traditional journalism funding models are facing unprecedented challenges. The decline of print advertising revenue, the rise of social media news consumption, and changing audience behaviors [...]
Navigating the Landscape of Journalism Scholarships: Opportunities Awaiting Aspiring Journalists
Uncovering the World of Journalism ScholarshipsIn the age of information, journalism stands as a pillar of democracy, providing the public with crucial insights and narratives that shape opinions and inform decisions. However, pursuing a career in this vital field can [...]
Exploring Context Graphs: The Future of AI Decision-Making
Understanding Context GraphsIn the rapidly evolving world of artificial intelligence, one concept is emerging as a potential game-changer: context graphs. These innovative structures offer a new way to capture decision traces, exceptions, precedents, and cross-system signals, shedding light [...]
Harnessing AI and Emerging Technologies in the Media Industry: Trends and Innovations for 2024
The Evolution of Media Through AI TechnologyIn the ever-evolving media landscape, artificial intelligence (AI) is reshaping the way content is created, distributed, and consumed. As we step into 2024, the integration of AI in the media industry is [...]
Navigating the Future of Journalism Funding: Opportunities and Innovations
The Shifting Landscape of Journalism FundingIn an era where misinformation spreads like wildfire, the role of journalism has never been more critical. However, the financial stability of this vital institution is under unprecedented threat. As traditional funding models [...]
Unlocking Opportunities: A Guide to Journalism Scholarships and Fellowships
The Path to Becoming a JournalistIn an era where information is currency, aspiring journalists find themselves at a crossroads of opportunity and challenge. The journey into the world of journalism is not just about passion; it often requires [...]
Unlocking the Power of Media Fellowships: A Pathway to Professional Growth
Discovering Media FellowshipsIn an era where storytelling is at the forefront of social change, media fellowships are emerging as essential avenues for emerging journalists and media professionals. These programs offer not just financial support, but also invaluable mentorship and networking [...]
Unlocking Opportunities: The Transformative Power of Journalism Fellowships
The Path Less Traveled: Understanding Journalism FellowshipsIn the landscape of modern journalism, fellowships have emerged as a beacon of opportunity for aspiring journalists and seasoned professionals alike. These programs not only provide financial support but also serve as [...]
The Shifting Landscape of AI: Insights from the Manus and Groq Acquisitions
Unpacking the New Dynamics of AI CompetitionIn early 2026, the artificial intelligence landscape underwent a seismic shift, marked by two pivotal acquisitions: Meta's $2 billion purchase of Manus and Nvidia's staggering $20 billion licensing deal with Groq. These transactions not [...]
Transforming the Media Landscape: The Latest Innovations in Technology
Emerging Technologies Shaping the Future of MediaAs the media industry evolves, the integration of new technologies is reshaping how content is created, distributed, and consumed. A pivotal shift is underway, driven by advancements in artificial intelligence (AI), cloud [...]
Exploring New Frontiers in Journalism Funding: Innovations and Opportunities
The Shifting Landscape of Journalism FundingIn an era where traditional media outlets are struggling to maintain their foothold, the landscape of journalism funding has evolved dramatically. With the rise of digital platforms and changing consumer behaviors, innovative funding [...]
Unlocking Opportunities: A Comprehensive Guide to Journalism Scholarships and Fellowships
Exploring the Landscape of Journalism ScholarshipsIn the fast-evolving world of journalism, aspiring journalists are often faced with the daunting challenge of financing their education. As the media landscape expands, so does the need for fresh talent equipped with [...]
Claude Code: The Future of Software Engineering and AI Infrastructure
Unleashing the Power of AI in Software DevelopmentIn an era where artificial intelligence (AI) is reshaping industries, the recent announcement that Claude Code is now capable of writing its own code marks a pivotal moment in software engineering. [...]
Unlocking Opportunities: A Comprehensive Guide to Media Fellowships
Understanding Media FellowshipsIn an era where information flows ceaselessly, media fellowships stand as pivotal avenues for aspiring journalists and media professionals. They offer not just financial support but invaluable mentorship, training, and networking opportunities that can significantly elevate one’s career [...]
Navigating the Future: How AI and Emerging Technologies are Transforming the Media Industry
Emerging Technologies Reshape the Media LandscapeAs the world becomes increasingly interconnected through digital platforms, the media industry is undergoing a profound transformation. Emerging technologies, particularly artificial intelligence (AI), are reinventing how content is created, distributed, and consumed. From [...]
Unlocking Opportunities: The Impact of Journalism Fellowships
The Transformative Power of Journalism FellowshipsIn a world where the media landscape is continually evolving, journalism fellowships have emerged as a beacon of opportunity for aspiring storytellers. These fellowships not only provide financial support and mentorship but also [...]
Funding the Future of Journalism: Navigating New Avenues
Journalism's Financial Landscape: A Shift in ParadigmIn an era where the integrity of information is paramount, the financial underpinnings of journalism are undergoing a seismic shift. Traditional funding models are struggling to keep up with the rapid evolution [...]
Unlocking Opportunities: A Guide to Journalism Scholarships and Fellowships
The Gateway to Your Journalism CareerIn the ever-evolving world of journalism, aspiring reporters and media professionals often find themselves at a crossroads: the passion for storytelling meets the daunting reality of tuition fees and student loans. Fortunately, a [...]
The Versatility of the Hamburger Menu in Modern Web Design
Unpacking the Hamburger Menu: A Modern Web Design EssentialIn the dynamic realm of tech and web design, the hamburger menu has emerged as a symbol of simplicity and efficiency. This minimalist icon, resembling its namesake, has become a [...]
Navigating the Future: The Role of AI and Emerging Technologies in the Media Industry
The Evolution of Media through TechnologyAs we stand on the precipice of a new era in media, the infusion of artificial intelligence (AI) and other emerging technologies is reshaping how content is created, consumed, and monetized. The media [...]
Exploring Innovative Funding Solutions for Journalism in the Digital Age
The Evolving Landscape of Journalism FundingIn an era where traditional revenue streams for news organizations are dwindling, the search for innovative funding solutions in journalism has become more crucial than ever. As print media wanes, digital platforms have [...]
Unlocking Opportunities: A Comprehensive Guide to Journalism Scholarships and Fellowships
A World of Possibilities for Aspiring JournalistsEvery aspiring journalist dreams of making a mark in a field driven by truth, creativity, and storytelling. However, the path to becoming a successful journalist is often paved with financial hurdles. Fortunately, [...]
Exploring Journalism Fellowships: Opportunities and Impact
Unlocking the World of Journalism FellowshipsIn the ever-evolving landscape of journalism, fellowships have emerged as invaluable gateways for aspiring journalists to gain experience, enhance their skills, and create impactful narratives. These programs not only provide financial support but [...]
5 Tech Trends That Will Shape 2026: Insights and Predictions
The Evolution of Smartphone PricingAs we approach 2026, the landscape of smartphone pricing is set to undergo significant changes. With the increasing saturation of the smartphone market, manufacturers are likely to adopt more competitive pricing strategies. This shift [...]
Trends That Will Shape the Year Ahead: Insights from CES 2026
Understanding the Future of TechnologyThe Consumer Electronics Show (CES) has long been a platform for unveiling the latest innovations and setting the stage for technological trends. As we look towards CES 2026, the insights gathered from various industry [...]
Emerging Tech Trends to Watch in 2026
1. The Rise of AI-Driven PersonalizationAs artificial intelligence continues to evolve, we can expect a significant increase in AI-driven personalization across various sectors. From e-commerce to entertainment, businesses are leveraging AI algorithms to tailor experiences to individual preferences. This not [...]
Exploring the Future of Embedded Technology
The Rise of Embedded TechnologyEmbedded technology has revolutionized various industries by integrating computing capabilities directly into devices. This seamless interaction enhances functionality and efficiency, allowing for smarter solutions across sectors such as healthcare, automotive, and consumer electronics. As we delve [...]
Harnessing the Power of Manifestation: A Comprehensive Guide
Understanding ManifestationManifestation is the process of turning your dreams and desires into reality through focused intention and belief. This concept can be traced back to ancient philosophies and has gained significant traction in modern self-help and personal development circles. The [...]
Key Social Media Trends to Watch in 2023
IntroductionAs we step into 2023, the landscape of social media continues to evolve at a rapid pace. Businesses and marketers must stay abreast of the latest trends to remain competitive. This article explores the key social media trends [...]
Understanding Journalism Funding: Navigating the Financial Landscape of News Media
The Evolving Landscape of Journalism FundingIn an era where the digital revolution has transformed how we consume news, journalism funding has become a critical aspect of maintaining the integrity and sustainability of media outlets. With traditional revenue streams [...]
AI New Year’s: A 10-Week Journey to AI Fluency
Embracing AI: A Pathway to MasteryAs we stand at the threshold of a new era in technology, the integration of artificial intelligence (AI) into our daily lives becomes increasingly vital. The final episode of 2025, titled 'AI New [...]
Navigating the World of Journalism Scholarships and Fellowships
The Lifeline of Journalism: Scholarships and FellowshipsIn an age where the voice of journalism faces unprecedented challenges, aspiring journalists are more than ever in need of financial support. Scholarships and fellowships have emerged as vital resources, offering budding [...]
Revolutionizing the Media Landscape: The Role of AI and Emerging Technologies
The Transformative Power of AI in MediaIn an age where information is as potent as gold, the media industry finds itself at the brink of a technological renaissance. Artificial Intelligence (AI) is not just a buzzword; it is [...]
Welcoming 2026: A Year of New Beginnings and Opportunities
A Joyful Start to 2026As the clock strikes midnight on December 31, 2025, the world comes alive with fireworks, laughter, and the promise of new beginnings. In a recent video titled HAPPY NEW YEAR 2026, viewers are greeted [...]
Emerging Social Media Trends for 2023: A Comprehensive Analysis
Understanding Social Media TrendsAs we progress through 2023, social media continues to evolve at an unprecedented pace. Staying informed about the latest trends is crucial for brands and marketers looking to maintain relevance in a crowded digital landscape. [...]
Media Trends Reshaping Entertainment in 2026
Introduction to Media TrendsThe entertainment landscape is undergoing a significant transformation as we approach 2026. With advancements in technology and shifts in consumer behavior, new media trends are emerging that promise to redefine how content is created, distributed, and consumed. [...]
Emerging Trends in Technology and Media for 2026
Overview of 2026 TrendsAs we approach 2026, various sectors are poised for transformation, driven by technological advancements and evolving consumer preferences. This article explores key trends in technology and media that will redefine our experiences and interactions in the coming [...]
AI in 2026: Predictions and Possibilities for a Transformative Future
Overview of AI's Expected Evolution As we look toward 2026, the landscape of artificial intelligence (AI) is set to undergo transformative changes. Experts from various fields, including technology, economics, and sociology, have made predictions that range from automation advancements to [...]
The Future of Journalism: Predictions for 2026
Transformative Trends Shaping Journalism As we start 2026, the landscape of journalism is poised for significant transformation, driven by technological advancements, shifting audience expectations, and the ever-evolving socio-political climate. Various thought leaders, including those from Nieman Lab and other industry [...]
Transforming the Media Landscape: Emerging Technologies and Trends for 2024
The New Frontier of Media: A Technological EvolutionIn an age defined by rapid technological advancements, the media industry is undergoing a transformative shift, reshaping how content is created, distributed, and consumed. With the integration of artificial intelligence (AI), cloud technology, [...]
Unlocking Opportunities: A Comprehensive Guide to Journalism Scholarships and Fellowships
Discovering the World of Journalism ScholarshipsIn an era where information is king, aspiring journalists are faced with both immense opportunities and significant financial burdens. The pursuit of a journalism degree can be daunting, with tuition fees often acting as a [...]
AI vs Human: The Unforgettable Dance Battle
You can listen to this article. The Dance Floor ShowdownIn a groundbreaking display of creativity and technology, a recent viral video titled "AI VS HUMAN. WHO WON DANCE BATTLE?" has captivated audiences around the globe. This short yet impactful [...]
Unlocking Opportunities: Your Guide to Journalism Scholarships and Fellowships
You can listen to this article. Funding Your Future in JournalismThe world of journalism is both exhilarating and challenging. Aspiring journalists often find themselves navigating a maze of educational requirements and financial hurdles. However, a multitude of scholarships and [...]
Navigating the Future: The Role of AI and Emerging Technologies in the Media Industry
You can listen to this article. The Digital Revolution and Its Impact on MediaAs the digital landscape evolves at an unprecedented pace, the media industry finds itself at the forefront of this transformation. From artificial intelligence to immersive technologies, [...]
Garmin Venu 4 Review — The Glow-Up We’ve Been Waiting For
You can listen to this article. Unveiling the Garmin Venu 4: A New Era of Fitness TrackingIn a world where health and fitness technology is rapidly evolving, the Garmin Venu 4 emerges as a beacon of innovation and style. [...]
Maximize Your Learning Potential with Ultimate Me
You can listen to this article. Unlock Your Learning Journey In today's fast-paced world, the quest for knowledge is more important than ever. Lifelong learning is no longer just a concept; it's a necessity for personal and professional [...]
Makerere University Honors Literary Giants at Annual Celebration
You can listen to this article. Celebrating Literary ExcellenceMakerere University, one of Africa's oldest and most prestigious institutions of higher learning, recently hosted a grand celebration honoring the contributions of literary giants to the field of literature. This event, [...]
Profile of Yaaka Digital Learning: Bridging Education and Technology in Uganda
You can listen to this article. Overview of Yaaka Digital Learning Yaaka Digital Learning is a comprehensive digital education platform designed to enhance learning outcomes in Uganda. It offers various resources aimed at both educators and students, focusing [...]
Harnessing the Power of Manifestation: A Guide to Becoming Your Ultimate Self
You can listen to this article. Understanding ManifestationManifestation is the process of turning your thoughts and desires into reality. It is based on the premise that our thoughts have power and can influence our life experiences. By focusing on [...]
Garmin Venu 4 Review — The Glow-Up We’ve Been Waiting For
Unveiling the Garmin Venu 4: A Game-Changer in Fitness TechnologyWith anticipation building among fitness enthusiasts and tech aficionados alike, Garmin has officially unveiled the Venu 4—a smartwatch that promises to redefine the standards of health and fitness tracking. This latest [...]
Garmin Venu 4 Review — The Glow-Up We’ve Been Waiting For
The Evolution of the Garmin Venu SeriesThe release of the Garmin Venu 4 marks a significant milestone in the evolution of Garmin's sports watch lineup. With its sleek design and advanced features, this smartwatch is more than just an upgrade; [...]
Garmin Venu 4 Review: The Glow-Up We’ve Been Waiting For
The New Standard in Fitness SmartwatchesThe Garmin Venu 4 has arrived, and with it comes a wave of excitement from fitness enthusiasts and tech lovers alike. This latest iteration in Garmin's popular Venu lineup not only builds on the solid [...]
Garmin Venu 4 Review — The Glow-Up We’ve Been Waiting For
The Garmin Venu 4: A Revolutionary UpgradeThe world of smartwatches is rapidly evolving, and the Garmin Venu 4 stands at the forefront of this revolution. With its sleek design and advanced features, it promises to be more than just a [...]
Stromme Foundation Pledges Support for Vulnerable Households in Uganda
You can listen to this article. Stromme Foundation's CommitmentIn a recent announcement, Dinah Morgan, the Country Director of Stromme Foundation, reaffirmed the organization's dedication to supporting vulnerable households across Uganda. The pledge comes amidst growing concerns regarding economic challenges [...]
Garmin Venu 4 Review — The Glow-Up We’ve Been Waiting For
Unveiling the Garmin Venu 4The highly anticipated Garmin Venu 4 has finally landed, and it's more than just a new addition to the Venu lineup; it’s a significant glow-up. Designed to cater to both everyday users and serious fitness enthusiasts, [...]
Garmin Venu 4 Review: The Glow-Up We’ve Been Waiting For
The Arrival of the Garmin Venu 4In the world of fitness technology, few brands resonate as powerfully as Garmin. Their latest release, the Garmin Venu 4, has generated significant buzz, promising enhancements that could redefine the user experience. The Venu [...]
Harnessing the Power of Manifestation: A Global Perspective on Learning and Growth
The Rise of Manifestation Techniques in EducationIn recent years, the concept of manifestation has gained significant traction across various sectors, notably in education. The idea that individuals can attract positive outcomes through focused intention and belief systems has sparked interest [...]
Garmin Venu 4 Review: The Glow-Up We’ve Been Waiting For
The Next Level in Fitness TrackingThe Garmin Venu 4 has arrived, marking a significant evolution in the Venu lineup. This new model is not just a minor update; it represents a comprehensive makeover that fitness enthusiasts have been eagerly anticipating. [...]
The iPhone 17e: Apple’s Game-Changer for 2026
The Excitement Around iPhone 17eThe tech world is buzzing with anticipation as leaks and rumors swirl around Apple’s forthcoming iPhone 17e. Unlike its predecessors, this model is poised to capture attention not just for its brand name but for a [...]
GoPro MAX 2 Review: The Ultimate 8K 360 Action Camera
Revolutionizing the Action Camera ExperienceThe GoPro MAX 2 has arrived, and it promises to redefine the landscape of action cameras with its stunning 8K 360-degree video capabilities. If you’re an adrenaline junkie or a content creator, the anticipation around this [...]
Unleashing the Power of 8K: A Comprehensive Review of the GoPro MAX 2
A New Era of Action CamerasThe GoPro MAX 2 has officially arrived, and it promises to redefine the landscape of 360° action cameras. Known for its unparalleled versatility and high-quality output, GoPro's latest offering is brimming with features that are [...]
The Future of FPV Drones: Unveiling the DJI Avata 360
Revolutionizing Aerial FilmmakingAs the sun dips below the horizon, casting a warm glow over the landscape, the promise of a new era in aerial photography looms large on the horizon with the impending release of the DJI Avata 360. Speculated [...]
DJI Avata 360: The Future of FPV Drones Unveiled
The Unveiling of the DJI Avata 360In a world where aerial photography and filmmaking are increasingly becoming integral to storytelling, drone technology continues to evolve at a breathtaking pace. Enter the DJI Avata 360, a drone that promises to redefine [...]
DJI Avata 360: The Future of FPV Drones Unveiled
The Excitement Surrounding the DJI Avata 360The drone industry is buzzing with anticipation as DJI prepares to unveil its most ambitious FPV (First-Person View) drone yet, the DJI Avata 360. This innovative device promises to redefine aerial photography and videography, [...]
The Exciting Future of Aerial Cinematography: Unveiling the DJI Avata 360
DJI Avata 360: A Game Changer in FPV DronesIn the ever-evolving world of drone technology, DJI has consistently pushed the boundaries of what is possible, and the upcoming DJI Avata 360 is no exception. This ambitious FPV drone promises to [...]
Unveiling the DJI Avata 360: A New Era in FPV Drones
The Anticipation Builds for the DJI Avata 360As rumors swirl and excitement mounts, the DJI Avata 360 is set to redefine the landscape of first-person view (FPV) drones. With official specifications, pricing, and a release date gradually coming into focus, [...]
Unveiling the DJI Avata 360: Specs, Price, and Release Insights
The Future of FPV DronesAs the drone market continues to evolve, DJI stands at the forefront of innovation, particularly with its latest venture into the realm of FPV (First Person View) technology. The buzz surrounding the DJI Avata 360 is [...]
The DJI Avata 360: A New Era in FPV Drones
The Future of Aerial PhotographyIn the ever-evolving world of drone technology, DJI has once again set the stage for innovation with the anticipated release of the DJI Avata 360. This drone promises to be a game-changer for enthusiasts and professionals [...]
DJI Avata 360: The Future of FPV Drones Unveiled
The Dawn of a New Era in Aerial PhotographyAs the sun illuminates the vast expanse of the sky, the world of aerial photography witnesses a transformative leap with the impending arrival of the DJI Avata 360. This latest innovation from [...]
DJI Avata 360: The Future of FPV Drones Unveiled
Revolutionizing FPV Flight with DJI Avata 360The buzz surrounding the DJI Avata 360 is palpable, as enthusiasts and creators alike anticipate what could be one of the most groundbreaking drones in the FPV (First Person View) market. As DJI continues [...]
DJI Avata 360: The Next Frontier in FPV Drones
The Future of FPV DronesThe anticipation surrounding the DJI Avata 360 is palpable, marking a pivotal moment in the world of first-person view (FPV) drones. With an array of rumors and leaks surfacing, this new addition to DJI's lineup could [...]
The Unveiling of the DJI Avata 360: Specs, Price, and Release Insights
DJI Avata 360: A Revolutionary Leap in FPV DronesAs the sun dips below the horizon, casting a golden hue across the landscape, a new era in aerial photography is set to take flight. The DJI Avata 360, a potential game-changer [...]
The DJI Avata 360: A Game Changer in FPV Drone Technology
Breaking New Ground in FPV DronesIn an era where technology evolves at breakneck speed, DJI seems poised to redefine the landscape of first-person view (FPV) drones with the upcoming DJI Avata 360. This ambitious drone is not just another addition [...]
Unveiling the DJI Avata 360: Specs, Price, and Release Date Insights
The Future of FPV Drones: Introducing DJI Avata 360In an era where aerial photography and videography are becoming increasingly sophisticated, the DJI Avata 360 emerges as a groundbreaking contender in the FPV drone market. This drone promises to blend high-quality [...]
DJI Avata 360: The Future of FPV Drones Unveiled
Unveiling the DJI Avata 360: A Game Changer in FPV DronesThe world of first-person view (FPV) drones is on the verge of a revolution. Enter the DJI Avata 360, a drone that is not just a mere upgrade but a [...]
DJI Avata 360: The Future of FPV Drones Unveiled
The Future is Here: DJI Avata 360In a world where immersive experiences are becoming the norm, the anticipation surrounding the DJI Avata 360 reaches new heights. This innovative drone promises to blend the realms of aerial cinematography and first-person view [...]
The Future of Aerial Cinematography: Unveiling the DJI Avata 360
The Anticipation for the DJI Avata 360As whispers of the DJI Avata 360 circulate through the drone enthusiast community, excitement reaches a fever pitch. This innovative FPV drone promises to blend the artistry of 360-degree cinematography with the exhilarating experience [...]
DJI Avata 360: The Next Frontier in FPV Drones
Unveiling the DJI Avata 360The whispers have grown into a crescendo, and the anticipation surrounding the DJI Avata 360 is palpable. Drone enthusiasts and creators alike are abuzz with speculation about DJI's most ambitious FPV drone to date. In a [...]
DJI Avata 360: The Future of FPV Drones Unveiled
The Dawn of a New Era in FPV DronesIn the ever-evolving world of aerial technology, DJI has consistently set benchmarks that redefine the standards of drone capabilities. The latest buzz surrounding the DJI Avata 360 hints at an ambitious leap [...]
DJI Avata 360: The Future of FPV Drones Unveiled
Revolutionizing Aerial FilmmakingThe DJI Avata 360 is not just another drone; it represents a pivotal moment in the evolution of first-person view (FPV) technology. As the whispers of its specifications and features grow louder, enthusiasts and content creators alike are [...]
The Future of Aerial Cinematography: Unveiling the DJI Avata 360
Revolutionary Design Meets Cutting-Edge TechnologyThe world of aerial cinematography is on the cusp of transformation, and at the heart of this evolution is the DJI Avata 360. This ambitious FPV (First-Person View) drone promises to merge cinematic 360-degree capture with [...]
Apple’s Foldable Future: The iPhone Fold Strategy Unveiled
Revolutionizing the Smartphone ExperienceIn an era where innovation reigns supreme, Apple is set to redefine the smartphone landscape with its much-anticipated foldable device—the iPhone Fold. As excitement builds around this groundbreaking product, the tech community buzzes with speculation and analysis, [...]
The iPhone Fold Strategy: A New Era for Apple
Revolutionizing the Smartphone LandscapeAs whispers of a foldable iPhone grow louder, Apple's strategy to introduce the iPhone Fold promises to redefine our relationship with smartphones. This anticipated device, which some reports suggest may debut with the iPhone 17 Fold or [...]
The iPhone Fold: Apple’s Strategic Leap into the Future
A New Era of InnovationThe tech world is buzzing with anticipation as Apple edges closer to unveiling one of its most revolutionary products yet: the iPhone Fold. This device promises to not only redefine the iPhone but also reshape the [...]
The Future of Foldable Technology: iPhone Fold Strategy Revealed
Unfolding the Future: The iPhone Fold StrategyThe anticipation surrounding Apple's entry into the foldable smartphone market is reaching a fever pitch. With whispers of the iPhone Fold becoming a reality, tech enthusiasts and loyal Apple fans alike are eager to [...]
Canon R6III vs Sony A7V: The Ultimate Mirrorless Camera Showdown
Two Titans in the Mirrorless ArenaIn the constantly evolving world of photography, two names reign supreme: Canon and Sony. The recent release of the Canon R6 III has sparked a heated debate among photographers and videographers alike, especially when pitted [...]
Canon R6III vs Sony A7V: A Comprehensive Comparison for Photographers and Videographers
Setting the Stage for a Camera ClashIn the ever-evolving world of photography and videography, choosing the right camera can feel overwhelming, especially with giants like the Canon R6 III and Sony A7V leading the charge. As the year 2025 unfolds, [...]
Canon R6 III vs Sony A7 V: A Comprehensive Comparison of Two Titans
The Clash of the Titans: Canon R6 III vs Sony A7 VIn the ever-evolving world of photography and videography, the battle between Canon and Sony continues to ignite passion among enthusiasts and professionals alike. The recent video comparison of the [...]
Canon R6 III vs Sony A7V: The Ultimate Camera Showdown
The Great Camera Debate of 2025In the ever-evolving world of photography, the competition between Canon and Sony has never been fiercer. As we step into 2025, the Canon R6 III and Sony A7V have emerged as two of the most [...]
Emerging Technologies Reshaping the Media Landscape in 2024
The Digital Renaissance: How Technology is Transforming Media in 2024As the sun rises each day, a new wave of technology washes over the media landscape, bringing with it a blend of challenges and opportunities. The year 2024 stands as a [...]
Navigating the Future: AI and Emerging Technologies Transforming the Media Industry
Revolutionizing Media Through TechnologyIn a rapidly evolving landscape, the media industry stands at the forefront of technological innovation. From artificial intelligence (AI) to immersive experiences, new technologies are reshaping how content is created, distributed, and consumed. As consumers demand more [...]
Navigating the Future: The Role of AI and Emerging Technologies in the Media Industry
Transformative Forces Shaping Media in 2024As the sun dipped below the horizon, casting an orange glow across the skyline, the media industry stood at the precipice of a new era. Emerging technologies and artificial intelligence (AI) have woven themselves intricately [...]
Navigating the Future of Media: The Impact of Emerging Technologies
Transforming the Media LandscapeAs technology continues to evolve at a breakneck speed, the media industry finds itself at a crucial crossroads. The convergence of artificial intelligence (AI), cloud technology, and advanced data analytics is reshaping how media is consumed, created, [...]
Navigating the Future: How AI and Emerging Technologies are Transforming the Media Industry
The Dawn of AI in MediaIn the rapidly evolving landscape of the media industry, artificial intelligence (AI) has emerged not just as a tool but as a transformative force. From content creation to audience engagement, AI technologies are reshaping how [...]
5 Higher Ed Tech Trends to Watch
The Evolution of Higher Education Technology The landscape of higher education is constantly evolving, driven by technological advancements that enhance student engagement, streamline administrative processes, and optimize learning experiences. As institutions adapt to these changes, staying informed about the latest [...]
Maximizing Your Educational Opportunities Through Scholarships
Understanding Scholarships: A Pathway to Academic Success Scholarships represent a significant opportunity for students to alleviate the financial burden of higher education. They are awarded based on various criteria including academic merit, financial need, and specific talents or backgrounds. With [...]
Exploring Scholarships and Awards at UNM: A Comprehensive Guide
Understanding the Importance of Scholarships Scholarships are crucial for students seeking financial assistance to further their education. They not only alleviate financial burdens but also open doors to opportunities that enhance academic and professional development. The University of New Mexico [...]
A Comprehensive Guide to Journalism Scholarships
Understanding Journalism Scholarships Journalism scholarships are financial awards designed to assist students pursuing a degree in journalism or related fields. These scholarships can significantly alleviate the financial burden of tuition and help aspiring journalists focus on their education and career [...]
Comprehensive Guide to Journalism Scholarships
Understanding Journalism Scholarships Journalism scholarships are essential financial aids that support aspiring journalists in pursuing their education. These scholarships are offered by various institutions, organizations, and foundations, aiming to promote excellence in journalism and provide opportunities for students from diverse [...]
Financial Strain on Parents as Schools Demand 70% Fees Payment Amid Economic Challenges
Increasing Financial Demands on Parents In a pressing issue affecting families across the country, schools are now requesting parents to pay 70% of their children’s tuition fees upfront. This development has raised concerns among parents who are already grappling with [...]
Harnessing AI and Emerging Technologies in the Media Industry: A 2024 Perspective
Revolutionizing Media: The Role of AIIn the rapidly evolving world of media, artificial intelligence (AI) is emerging as a transformative force. From content creation to audience engagement, AI technologies are reshaping how media companies operate and connect with their audiences. [...]
Unveiling the Hidden Treasures of Apple TV’s tvOS 26 Update
Revolutionizing Your Streaming ExperienceAs the digital landscape evolves, so too does our need for seamless entertainment solutions. The latest update to Apple TV, the tvOS 26, has arrived, bringing with it an array of features that promise to [...]
Unveiling the Secrets of Apple TV’s tvOS 26.2 Update
A New Era for Apple TV 4KAs the digital landscape continuously evolves, Apple TV aims to stay at the forefront with its latest software updates. The release of tvOS 26.2 has sparked excitement among users, promising a host of new [...]
Exploring the New Horizons of Apple TV with tvOS 26.2
Unveiling the Future: What’s New in tvOS 26.2In the fast-evolving world of streaming technology, Apple TV continues to redefine the viewing experience for its users. The recent update to tvOS 26.2 has stirred excitement among Apple enthusiasts, unveiling a suite [...]
Unveiling the Secrets of Apple TV’s tvOS 26: Features You Can’t Miss
The Dawn of tvOS 26In the ever-evolving landscape of streaming technology, Apple has consistently set the bar high. With the recent release of tvOS 26, Apple TV 4K users are in for a treat. This update is not just another [...]
Unveiling the New Features of Apple TV tvOS 26: What You Need to Know
Major Changes in Apple TV tvOS 26As the digital landscape evolves, so too does Apple’s commitment to enhancing user experience through innovative updates. The latest iteration, tvOS 26, has surfaced with a plethora of new features that promise to redefine [...]
Unveiling the New Features of Apple TV tvOS 26.2: What You Need to Know
Revolutionizing Your Viewing ExperienceApple TV has always set the bar high when it comes to streaming devices, and with the release of tvOS 26, it's raising it even higher. As users eagerly anticipate the latest features, the buzz surrounding the [...]
Exploring Journalism Scholarships: Opportunities for Aspiring Journalists
Understanding Journalism Scholarships Journalism scholarships serve as vital financial resources for students aspiring to enter the world of media and communication. These scholarships are designed to alleviate the financial burden of tuition and related expenses, allowing students to focus on [...]
Unveiling the Secrets of tvOS 26: What You Need to Know
A New Era for Apple TV: The tvOS 26 UpdateAs the world of streaming continues to evolve, Apple TV has remained a pivotal player in the game. With the recent release of tvOS 26, Apple has introduced a plethora of [...]
Apple Mac Mini M5 & M5 Pro (2026) – Everything We Know So Far
The Future is Compact: Apple Mac Mini M5 & M5 ProThe anticipation is palpable as tech enthusiasts and everyday users alike eagerly await the launch of the Apple Mac Mini M5 and M5 Pro, expected in 2026. As whispers of [...]
Insta360 Ace Pro 3: A Game-Changer in Action Cameras
The New Standard for Action CamerasAs the world of action cameras evolves, the Insta360 Ace Pro 3 emerges as a formidable contender, promising features that could redefine the market. Designed for adventurers and content creators alike, this camera is already [...]
Unveiling the Insta360 Ace Pro 3: The Ultimate Action Camera for Creators
The Next Generation of Action CamerasThe world of action cameras is on the brink of a significant evolution with the anticipated release of the Insta360 Ace Pro 3. Designed for creators ranging from vloggers to extreme sports enthusiasts, this camera [...]
Insta360 Ace Pro 3 – Everything You NEED to Know Before Buying!
Revolutionizing Action Cameras: The Insta360 Ace Pro 3As the sun sets over the horizon, casting a golden hue across the rugged landscape, adventure enthusiasts are gearing up for a new era in action cameras. Enter the Insta360 Ace Pro 3, [...]
Insta360 Ace Pro 3: Everything You NEED to Know Before Buying!
The Future of Action Cameras: Insta360 Ace Pro 3As the sun dipped below the horizon, casting a warm golden hue over a rugged landscape, a group of adventurers prepared to capture their thrilling journey with the latest innovation in action [...]
Unveiling the Insta360 Ace Pro 3: Your Ultimate Guide Before You Buy
Everything You Need to Know About the Insta360 Ace Pro 3In the ever-evolving world of action cameras, the Insta360 Ace Pro 3 emerges as a game-changer, setting the stage for a technological revolution in 2025. With whispers of impressive specifications [...]
Insta360 Ace Pro 3: Everything You Need to Know Before Buying
The Next Frontier in Action CamerasThe Insta360 Ace Pro 3 is on the verge of revolutionizing the action camera landscape. As enthusiasts eagerly await its release, the buzz surrounding its innovative features, high-performance capabilities, and competitive pricing creates an electrifying [...]
Insta360 Ace Pro 3: The Ultimate Action Camera You Need to Know About
Unveiling the Insta360 Ace Pro 3The world of action cameras is ever-evolving, and the Insta360 Ace Pro 3 stands at the forefront of this revolution. With whispers of 8K video capabilities and cutting-edge technology, this camera is poised to redefine [...]
Insta360 Ace Pro 3 – Everything You NEED to Know Before Buying!
The Future of Action Cameras: Insta360 Ace Pro 3In an era where capturing the world through a lens is more than just a hobby, the Insta360 Ace Pro 3 is positioned to revolutionize the action camera landscape. With advanced technology [...]
Insta360 Ace Pro 3: Everything You Need to Know Before Buying
Unleashing the Future of Action CamerasIn a world where adventure and creativity collide, the Insta360 Ace Pro 3 is poised to make waves in the action camera market. With its promise of advanced features and cutting-edge technology, this camera is [...]
Insta360 Ace Pro 3: Everything You Need to Know Before Buying
The Future of Action Cameras: Insta360 Ace Pro 3As the sun sets over the horizon, casting a golden hue across the landscape, adventure seekers are gearing up to capture their thrilling moments. Enter the Insta360 Ace Pro 3, an action [...]
Insta360 Ace Pro 3: Everything You Need to Know Before Buying
Unveiling the Future of Action CamerasThe world of action cameras is on the brink of transformation, and at the heart of this evolution is the much-anticipated Insta360 Ace Pro 3. Known for its innovative technology and user-friendly design, Insta360 is [...]
Insta360 Ace Pro 3: The Ultimate Action Camera You Need to Know About
Unveiling the Insta360 Ace Pro 3The buzz surrounding the Insta360 Ace Pro 3 has reached a fever pitch, and for good reason. Designed to elevate the standards of action cameras, this device promises a plethora of features that could redefine [...]
Insta360 Ace Pro 3: The Game-Changer in Action Cameras
The Insta360 Ace Pro 3: A Revolution in Action CamerasAs the sun dips below the horizon, casting a golden hue over the rugged landscape, adventure enthusiasts find themselves on the edge of their seats, eagerly anticipating the release of the [...]
Insta360 Ace Pro 3: Everything You Need to Know Before Buying
The Next Generation of Action CamerasIn the rapidly evolving world of action cameras, the Insta360 Ace Pro 3 is making waves and capturing the attention of both enthusiasts and professionals alike. With its promise of advanced technology and enhanced usability, [...]
Exploring the Future of Action Cameras: The Insta360 Ace Pro 3
Revolutionizing Action FilmmakingThe world of action cameras is poised for a major transformation with the anticipated release of the Insta360 Ace Pro 3. Promising to redefine the standards of video quality and creative capabilities, this device is set to rival [...]
Insta360 Ace Pro 3: The Next Generation of Action Cameras
The Future of Action PhotographyIn the ever-evolving world of action cameras, the Insta360 Ace Pro 3 is capturing the attention of enthusiasts and professionals alike. Set to redefine the standards for portable video recording, this camera is rumored to pack [...]
Tech and Learning Announces ISTE 2025 Best of Show Winners, Montana Tech Recognized in Money’s 2025 Best Colleges List
Tech and Learning Celebrates Innovation at ISTE 2025 The International Society for Technology in Education (ISTE) 2025 event has concluded with a showcase of groundbreaking educational technologies. Tech and Learning unveiled its prestigious 'Best of Show' winners, highlighting exceptional products [...]
Tech & Learning Announces Winners of Best of Show at ISTE 2025
Tech & Learning Unveils Winners at ISTE 2025 The annual International Society for Technology in Education (ISTE) conference has proven once again to be a hotspot for innovation in educational technology. This year, Tech & Learning has announced the winners [...]
The Intersection of Innovation and Education
Navigating the Future of Higher Education Technology As the landscape of higher education continues to evolve, institutions must adapt to the rapid pace of technological advancement. At the forefront of this evolution is the EDUCAUSE Annual Conference, where thought leaders [...]
Insta360 Ace Pro 3: The Future of Action Cameras
The Unveiling of the Insta360 Ace Pro 3As the sun sets over a bustling city, the excitement for the latest in action camera technology reaches a fever pitch. Enter the Insta360 Ace Pro 3, a device that promises to revolutionize [...]
Unveiling the Insta360 Ace Pro 3: The Action Camera of the Future
Meet the Insta360 Ace Pro 3In the ever-evolving world of action cameras, the Insta360 Ace Pro 3 is making waves. As rumors swirl and leaks emerge, this camera is poised to redefine the landscape of portable video recording. With a [...]
Insta360 Ace Pro 3: Everything You NEED to Know Before Buying!
Revolutionizing Action Cameras: The Insta360 Ace Pro 3As technology continues to advance at a breathtaking pace, the consumer landscape for action cameras is transforming rapidly. Enter the Insta360 Ace Pro 3, poised to set new standards in the realm of [...]
Insta360 Ace Pro 3: Everything You Need to Know Before Buying
Unveiling the Future of Action CamerasThe world of action cameras is about to be revolutionized with the impending release of the Insta360 Ace Pro 3. As rumors swirl and excitement builds, this camera promises to deliver groundbreaking features that could [...]
Insta360 Ace Pro 3: The Future of Action Cameras
The Dawn of a New Era in Action CamerasThe world of action cameras is on the brink of transformation with the anticipated release of the Insta360 Ace Pro 3. This device promises to redefine the standards set by its predecessors, [...]
The Future of Technology: Insights and Predictions for 2026
Technology's Dynamic LandscapeIn the ever-evolving realm of technology, staying ahead of the curve is not just beneficial but essential for businesses and individuals alike. As we glimpse into the future, predictions from reputable sources like Deloitte and Gartner provide a [...]
Insta360 Ace Pro 3: The Ultimate Action Camera Unveiled
Unleashing the Power of the Insta360 Ace Pro 3The world of action cameras is on the brink of a revolution, and at the forefront is the highly anticipated Insta360 Ace Pro 3. As we navigate through the maze of rumors, [...]
Insta360 Ace Pro 3: The Next Evolution in Action Cameras
The Future of Action Cameras is HereThe Insta360 Ace Pro 3 is not just another addition to the action camera market; it is poised to redefine the standards for what these devices can achieve. With the promise of cutting-edge features [...]
Revolutionizing Handheld Filmmaking: A Deep Dive into the DJI Pocket 4
The Dawn of the DJI Pocket 4With a sleek redesign and game-changing features, the DJI Pocket 4 has officially arrived, sending ripples through the world of handheld cameras. Packing a punch with its ability to shoot in stunning 8K resolution, [...]
DJI Pocket 4: The Game-Changing Gimbal Camera Unveiled
Unveiling the Future of Portable FilmmakingThe much-anticipated DJI Pocket 4 has finally hit the airwaves, captivating tech enthusiasts and content creators alike with its groundbreaking features and design. As the latest iteration in the revered Pocket series, this handheld gimbal [...]
DJI Pocket 4: A Game-Changer in Handheld Filmmaking
The Unveiling of DJI Pocket 4The buzz surrounding the DJI Pocket 4 is palpable, as enthusiasts and professionals alike eagerly await the official launch of this cutting-edge gimbal camera. With its promise of 8K video capabilities, a complete redesign, and [...]
DJI Pocket 4: The Game-Changer in Handheld Filmmaking
DJI Pocket 4: A New Era of Portable FilmmakingThe excitement surrounding the launch of the DJI Pocket 4 is palpable. As whispers of its capabilities and features circulate in the filmmaking community, the implications of this next-generation gimbal camera are [...]
DJI Pocket 4: The Game-Changing Gimbal Camera You’ve Been Waiting For
The Evolution of Compact FilmmakingIn an era where content creation is at an all-time high, the tools we use to capture our stories are evolving rapidly. Enter the DJI Pocket 4, a sleek, handheld gimbal camera that promises to redefine [...]
Navigating the Digital Revolution: How AI and Emerging Technologies are Shaping the Future of Media
The Digital Transformation of MediaIn an era where technology evolves at breakneck speed, the media industry stands at the forefront of this transformation. The integration of artificial intelligence (AI) and other emerging technologies is not just a trend; it is [...]
Navigating the Revolution: How AI and Emerging Technologies are Shaping the Media Industry in 2024
Transforming the Narrative: AI's Role in Media EvolutionAs the sun sets over the bustling city of New York, the skyline is lit not just by the lights of skyscrapers but by the innovation and creativity emanating from media companies adapting [...]
Navigating the Future: The Role of AI and Emerging Technologies in the Media Industry
The Evolution of AI in MediaAs the sun rises on a new era, the media industry finds itself at the crossroads of tradition and innovation. The rapid advancement of artificial intelligence (AI) is reshaping how content is created, consumed, and [...]
The Future of Media: How Emerging Technologies Are Reshaping the Landscape
Transforming the Media Landscape with TechnologyIn an era where information travels at the speed of light, the media industry is undergoing a seismic shift, driven by the relentless advancement of technology. From the rise of artificial intelligence to the integration [...]
Navigating the Future: The Role of Emerging Technologies in the Media Industry
The Digital Renaissance: How Technology is Transforming MediaAs the sun sets over the sprawling cityscape, a new dawn rises in the media industry. This transformation is not merely a shift in content delivery but a complete overhaul of how information [...]
Navigating the New Frontier: AI and Emerging Technologies in the Media Industry
The Dawn of AI in MediaAs the sun rises over the digital landscape, the media industry stands at a pivotal crossroads where artificial intelligence (AI) and emerging technologies are reshaping its very fabric. The narratives we consume, the platforms we [...]
Navigating the Media Landscape: How Emerging Technologies are Shaping the Future
The Dawn of a New Era in MediaAs the sun rises on a new decade, the media industry stands on the brink of transformation. Emerging technologies are not just augmenting traditional practices; they are redefining the very fabric of how [...]
Navigating the Future: How Emerging Technologies are Transforming the Media Industry
Transformative Technologies in MediaThe media landscape is undergoing a seismic shift, driven by a wave of technological advancements that are reshaping how content is created, distributed, and consumed. As we delve into 2024 and beyond, the convergence of artificial intelligence [...]
Transforming the Media Landscape: The Role of AI and Emerging Technologies
AI and the Media RevolutionAs the sun sets over bustling newsrooms and vibrant production studios, a silent revolution is taking place, powered by artificial intelligence (AI) and cutting-edge technologies. This transformation is not merely a trend; it marks a pivotal [...]
Transforming Media: The Role of AI and Emerging Technologies in Shaping the Future
Revolutionizing Media: The AI ImpactIn an era where information is at our fingertips, the media landscape is experiencing a radical transformation, driven primarily by advancements in artificial intelligence (AI) and emerging technologies. As the digital realm expands, media companies are [...]
Navigating the Transformative Landscape of AI and Technology in the Media Industry
The Dawn of AI in Media As the sun rises over the digital age, the media industry finds itself at the cusp of a technological revolution. With artificial intelligence (AI) evolving at an unprecedented pace, traditional media outlets are adapting [...]
Harnessing the Power of Manifestation: Insights from Influential Sources
Understanding Manifestation Manifestation is the process of turning your thoughts and desires into reality. It involves utilizing the power of your mind and emotions to attract what you want in life. This concept has been popularized in recent years through [...]
Navigating the Future: The Role of AI and Emerging Technologies in the Media Industry
Transforming Traditions: AI's Impact on Media In the bustling heart of modern media, where information flows faster than ever, the integration of artificial intelligence (AI) is reshaping the landscape. Gone are the days when journalists relied solely on pen and [...]
The Evolution of AI and Emerging Technologies in the Media Industry
The Transformative Role of AI in Media The media industry is undergoing a profound transformation, driven by advancements in artificial intelligence (AI) and emerging technologies. These innovations are reshaping how content is created, distributed, and consumed, leading to a more [...]
Harnessing AI and Emerging Technologies in the Media Landscape: Trends and Innovations for 2025
The Transformative Power of AI in Media The media landscape is undergoing a seismic shift, driven by the relentless march of artificial intelligence and emerging technologies. As we step into 2025, media companies are increasingly embracing AI to enhance content [...]
Navigating the Future: How AI and Emerging Technologies are Shaping the Media Industry
The Evolution of Media: Embracing AI and Emerging Technologies As the sun dips below the horizon, casting a golden glow over bustling newsrooms and studios, the media industry stands on the precipice of a technological revolution. The convergence of artificial [...]
The Transformative Role of AI and Emerging Technologies in the Media Industry
The Transformative Role of AI and Emerging Technologies in the Media Industry In an era characterized by rapid technological advancement, the media industry stands at the forefront of innovation, leveraging cutting-edge technologies to reshape how content is created, distributed, and [...]
The Future of AI in the Media Industry: Transformative Technologies and Trends for 2024
Introduction In the rapidly evolving landscape of the media industry, artificial intelligence (AI) stands out as a transformative force. As 2024 approaches, media companies are increasingly leveraging cutting-edge AI technologies to improve efficiency, enhance user engagement, and deliver personalized content. [...]
Emerging Technologies Transforming the Media Industry: A 2025 Perspective
Introduction The media industry is undergoing a profound transformation, spurred by the convergence of innovative technologies that reshape how content is created, distributed, and consumed. As we look towards 2025, understanding these advancements is crucial for industry stakeholders aiming to [...]
Navigating the Future: The Role of Emerging Technologies in the Media Industry
Introduction The media industry is undergoing a seismic shift, driven by rapid advancements in technology. As we move further into 2024 and beyond, understanding these emerging technologies is crucial for media companies aiming to stay relevant. From artificial intelligence to [...]
Harnessing AI: The Future of the Media Industry
Introduction: A Transformative Era in Media As we dive deeper into the 21st century, the media industry stands at the forefront of a technological revolution. The advent of artificial intelligence (AI), cloud computing, and emerging digital technologies is reshaping how [...]
The Transformation of the Media Industry Through Emerging Technologies
Introduction The media industry is undergoing a transformative phase driven by rapid advancements in technology. From artificial intelligence (AI) to cloud computing and blockchain, these technologies are not only reshaping how content is created and consumed but also redefining the [...]
Navigating the Future: How AI and Emerging Technologies are Transforming the Media Industry
The Intersection of AI and Media: A New Era of Content Creation The media industry is undergoing a seismic shift driven by artificial intelligence (AI) and emerging technologies. As traditional media paradigms give way to innovative solutions, companies are re-evaluating [...]
New Advancements in Manifestation Techniques: Exploring the Power of ‘Becoming the Ultimate Master’
Introduction In today’s fast-paced world, individuals are constantly seeking effective methods to enhance their personal and professional lives. One of the most intriguing areas of focus has been the art of manifestation, which involves the practice of turning dreams into [...]
The Classroom of 2025: Navigating the Future of Educational Technology
Introduction As we approach the mid-2020s, the landscape of education is undergoing a seismic shift, driven by rapid advancements in technology. The fusion of digital tools and teaching methodologies is shaping a new era, where classrooms are becoming more interactive, [...]
Game-Changing Technologies in Content Creation for Businesses
In an increasingly digital world, the landscape of content creation is evolving rapidly. Businesses are continually looking for innovative technologies that not only streamline production processes but also enhance the quality of their content. From automation tools to advanced [...]
The Revolutionary Impact of AI Technology in the Media Industry
The media industry is undergoing a seismic shift, driven primarily by advancements in artificial intelligence (AI) and other emerging technologies. From content creation to distribution, AI is reshaping how media organizations operate, engage with audiences, and deliver value. This article [...]
Revolutionizing Content Creation: Game-Changing Technologies for Businesses
The world of content creation is undergoing a profound transformation, driven by advancements in technology that empower businesses to produce compelling, engaging, and informative material like never before. As the demand for high-quality content escalates, innovation in tools and techniques [...]
The Future of Media: Navigating New Technologies and Trends in 2024
Introduction: Transforming the Media Landscape In the fast-paced world of media, change is the only constant. The convergence of technology and creativity has not only redefined how content is created and consumed but has also set the stage for an [...]
The Evolving Landscape of Media: How AI and Emerging Technologies are Reshaping the Industry
Introduction: A Paradigm Shift in Media The media landscape is undergoing a seismic shift, driven by the relentless march of technology. From artificial intelligence to innovative digital platforms, the way we consume and interact with media is evolving at a [...]
Embracing the Future: AI and Emerging Technologies in the Media Industry
The Dawn of a New Era in Media In a world where technology evolves at breakneck speed, the media industry stands on the precipice of a revolution. With artificial intelligence (AI) and cutting-edge technologies paving the way, media companies are [...]
The Evolution of AI in the Media Industry: Navigating New Frontiers
The Transformative Power of AI in Media In an age where technology is reshaping every facet of our lives, the media industry stands at the forefront of this transformation. Artificial Intelligence (AI) has emerged as a powerful catalyst, driving innovations [...]
The Digital Renaissance: How AI and Emerging Technologies are Shaping the Media Industry in 2024
Introduction: The Media Industry at a Crossroads The media industry has always been a reflection of society's values, aspirations, and challenges. However, as we move deeper into 2024, a seismic shift is underway, driven by artificial intelligence (AI) and emerging [...]
Exploring the Diverse World of Video Content: A Comprehensive Guide
? You can listen to podcast of this article: The digital landscape has been profoundly transformed by the rise of video content, which has become a pivotal medium for communication, education, and entertainment. As technology evolves, platforms like YouTube are [...]
The New Age of Journalism: Navigating the Digital Landscape
In an era marked by rapid technological advancement and digital transformation, journalism is undergoing a seismic shift. The traditional paradigms of news gathering and dissemination are being challenged, as digital platforms redefine how information is consumed and shared. This evolution [...]
Exploring the Modern Landscape of Journalism: Challenges and Opportunities in the Digital Age
The journalism industry is currently navigating a transformative era characterized by rapid technological advancements and evolving consumer expectations. This shift presents both challenges and opportunities for journalists, media organizations, and the broader public. The rise of digital media platforms has [...]
The Evolving Landscape of Journalism in the Digital Age
In an era where digital media has become pervasive, the landscape of journalism is undergoing a significant transformation. The rapid evolution of technology has not only changed how news is gathered and disseminated but also challenged traditional notions of who [...]
The Evolution of Journalism in the Digital Age
In the age of digital transformation, journalism is undergoing rapid changes that have reshaped how news is gathered, disseminated, and consumed. The integration of new media technologies has not only altered traditional journalism’s landscape but has also introduced new challenges [...]
The Evolution of Journalism in the Digital Age: Navigating New Media and Freelancing
In an era where digital platforms dominate the dissemination of information, the field of journalism is undergoing a seismic shift. The transformation is not merely technological but impacts the very essence of how news is gathered, reported, and consumed. Today's [...]
The Evolving Landscape of Journalism: Navigating New Media in the Digital Age
The rapid evolution of media in the digital age has reshaped the landscape of journalism, presenting new challenges and opportunities. Traditional journalism, once dominated by print newspapers and television broadcasts, now competes with a plethora of digital platforms that have [...]
The Evolution of Journalism in the Digital Age: Challenges and Opportunities
In the rapidly changing landscape of journalism, the digital age presents both daunting challenges and unprecedented opportunities. As traditional media outlets struggle to keep pace with technological advancements, new media platforms and freelance journalism have emerged as significant players in [...]
The Rise of New Media Journalism
Introduction: The Changing Face of Journalism The landscape of journalism has undergone a seismic shift in recent years, driven largely by the advent of digital platforms and social media. This transformation has not only altered how news is consumed [...]
The Evolving Landscape of Journalism in the Digital Age
The media landscape has undergone a seismic shift in recent years, driven largely by the relentless march of digital technology and the pervasive influence of social media. In this new paradigm, journalism has had to adapt rapidly, with both opportunities [...]
The Evolving Landscape of Journalism in the Age of Digital Media
As the digital era reshapes industries globally, journalism stands at a significant crossroads. The evolution from traditional media to new media has transformed the way news is produced, consumed, and perceived. With digital platforms becoming primary sources of information, [...]
The Evolving Landscape of Journalism in the Age of New Media
In an era where digital platforms have become the primary sources of news for millions, the landscape of journalism is undergoing a seismic shift. The traditional paradigms of news gathering, dissemination, and consumption are being redefined by the relentless pace [...]
The Evolution of Journalism in the Digital Age
The Evolution of Journalism in the Digital Age The Evolution of Journalism in the Digital Age In the rapidly evolving landscape of media, the role of journalism has never been more critical nor more challenging. As digital platforms continue to [...]
The Evolving Landscape of Journalism in the Digital Age
The digital age has ushered in a transformative era for journalism, reshaping how news is gathered, distributed, and consumed. As traditional media grapples with declining readership and advertising revenues, digital platforms offer both challenges and opportunities. This article explores various [...]
The Evolving Landscape of Media: Navigating Journalism in the Digital Age
The world of journalism is undergoing a seismic shift, driven by the relentless march of technology and the proliferation of digital platforms. At the heart of this transformation is the evolving definition of what it means to be a journalist [...]
The Evolving Landscape of New Media Journalism: Challenges and Opportunities
In the rapidly changing world of journalism, the emergence of new media has reshaped the landscape dramatically. Traditional journalism is continually being challenged by digital advancements, leading to significant shifts in how information is disseminated and consumed. This transformation presents [...]
The Evolution of Journalism in the Digital Age
In the modern era, journalism has undergone a significant transformation, primarily driven by the advent of digital media. This shift has not only altered how news is consumed but also how it is produced and disseminated. The transition from traditional [...]
The Evolution of Journalism in the Digital Age: Challenges and Opportunities
In a world where information is a mere click away, the landscape of journalism has undergone a seismic shift. With the rise of digital platforms, the traditional newsroom is no longer the gatekeeper of news. Instead, the power to disseminate [...]
The Evolution of Journalism in the Digital Age
The landscape of journalism has undergone a monumental shift with the advent of digital media. The traditional methods of news reporting are being challenged as new media platforms exert their influence over how information is disseminated and consumed. This transformation [...]
The Evolving Landscape of Freelance Journalism in the Age of Digital Media
The realm of journalism has undergone a seismic shift over the past decade as digital platforms have redefined how news is reported, disseminated, and consumed. With the advent of social media, citizen journalism, and digital storytelling, traditional media outlets face [...]
The Evolving Landscape of Journalism in the Age of Digital Media
In an era where information dissemination is instantaneous and global, the field of journalism is undergoing a seismic transformation. The advent of digital media has not only reshaped how news is consumed but also redefined who counts as a journalist. [...]
The Evolution of Journalism in the Age of Digital Media
In the ever-evolving landscape of journalism, the digital age has heralded a seismic shift in how news is gathered, disseminated, and consumed. With the rise of digital platforms and social media, traditional journalism faces new challenges and opportunities. This transformation [...]
The Evolving Landscape of Journalism in the Digital Age
In recent years, the landscape of journalism has undergone an unprecedented transformation. The rise of digital media and online platforms has not only changed how news is delivered but also how it is consumed. The advent of social media, blogs, [...]
The Evolution of Journalism in the Digital Age
As the world becomes increasingly digital, the landscape of journalism is evolving at an unprecedented rate. The rise of new media has transformed the way news is produced, disseminated, and consumed. This shift has brought about both opportunities and challenges [...]
The Evolution of Journalism in the Digital Age
In the fast-paced and ever-evolving world of journalism, the digital age has ushered in unprecedented changes that have redefined the landscape of news reporting. From the emergence of new media platforms to the challenges posed by social media, journalism today [...]
The Evolution and Challenges of New Media Journalism
In the past few decades, the landscape of journalism has undergone a seismic shift, largely due to the advent of digital and social media. The traditional pillars of journalism have been shaken, and new media has emerged as both a [...]
The Evolution of Journalism in the Digital Age
In the rapidly evolving landscape of media, journalism stands as a crucial pillar, adapting to the challenges and opportunities presented by new technologies. As we delve into the 21st century, the transformation of journalism is not just a trend but [...]
The Evolving Landscape of Journalism in the Digital Age
In an era where technology advances at an unprecedented speed, the field of journalism is experiencing profound transformations. The shift from traditional media to digital platforms has redefined how news is gathered, reported, and consumed. As these changes unfold, journalists [...]
The Evolution of Journalism in the Digital Age: Navigating the New Media Landscape
In an era where the media landscape is rapidly evolving, journalists face unprecedented challenges and opportunities. The digital age has transformed the way we consume and produce news, raising questions about the role of traditional journalism and the rise of [...]
The Evolution of Journalism in the Digital Age: Navigating the New Media Landscape
The landscape of journalism has undergone a seismic shift in the past few decades, primarily driven by the advent of digital and social media. This transformation has not only altered how news is reported and consumed but also posed significant [...]
The Evolving Landscape of Journalism in the Digital Age
In an era characterized by rapid technological advancements, the field of journalism is undergoing a significant transformation. The emergence of digital platforms, social media, and new storytelling techniques has reshaped the way journalists gather, produce, and disseminate information. This evolution [...]
The Evolution of Journalism in the Digital Age: Navigating New Media Landscapes
In the rapidly evolving landscape of journalism, the digital age has ushered in unprecedented changes. As traditional news outlets grapple with the challenges posed by new media, journalists find themselves at the crossroads of innovation and ethical responsibility. This transformation [...]
The Evolution of Journalism in the Digital Age
Journalism has long been a critical component of democratic societies, serving as a watchdog, a source of information, and a platform for discourse. However, the digital age has profoundly transformed the landscape of journalism, bringing both unprecedented opportunities and formidable [...]
The Evolution of Journalism in the Digital Age
In the ever-evolving landscape of journalism, the influence of digital media has been profound, reshaping how news is gathered, reported, and consumed. As traditional boundaries blur, the role of the journalist is undergoing significant transformation. This article delves into the [...]
The Evolving Landscape of Journalism in the Digital Age
In an era defined by rapid technological advancement, the landscape of journalism is undergoing a seismic transformation. Digital platforms have democratized the flow of information, empowering citizen journalists and expanding the reach of traditional media. However, this evolution also presents [...]
The Evolution of Journalism in the Digital Age
The landscape of journalism has undergone significant metamorphosis with the advent of digital and social media. Traditional media outlets, once the gatekeepers of news, have seen their authority challenged by the rapid dissemination of information across digital platforms. This shift [...]
The Evolution and Challenges of Journalism in the Digital Age
In the rapidly evolving landscape of journalism, the transition from traditional media to digital formats has not only transformed how news is disseminated but also reshaped the very core of journalistic practices. As platforms and technologies continue to advance, journalists [...]
The Evolution of Journalism in the Digital Age
As the landscape of media continues to evolve, journalism finds itself at an integral crossroads, poised between traditional methods and the burgeoning field of digital media. This transformation is not merely a shift in medium but a profound change in [...]
The Evolution of Journalism in the Digital Age
In an era where the traditional boundaries of journalism are continually being redefined, understanding the landscape of digital media is more critical than ever. As the internet becomes increasingly entrenched in our daily lives, the way we consume news [...]
Adapting to the New Media Landscape: A Guide for Journalists
In the rapidly evolving world of journalism, the rise of digital and social media platforms has reshaped the way news is produced, consumed, and perceived. As traditional media outlets grapple with declining readership and advertising revenues, journalists are increasingly turning [...]
The Evolution of Journalism in the Digital Age: Challenges and Opportunities
In the rapidly evolving landscape of digital media, journalism is undergoing transformative changes. As traditional models of news dissemination are disrupted by digital platforms, journalists are faced with new challenges and opportunities. This article delves into the complexities of freelancing [...]
Exploring the New Frontier: Journalism in the Digital Age
Exploring the New Frontier: Journalism in the Digital Age The landscape of journalism is undergoing a seismic shift, driven by the relentless pace of digital innovation and the proliferation of new media platforms. As traditional media grapples with declining revenues [...]
The Transformative Landscape of New Media Journalism: Navigating Freelancing, Digital Challenges, and Opportunities
In the ever-evolving realm of journalism, the advent of new media has revolutionized the way information is disseminated and consumed. From the rise of digital platforms to the increasing prevalence of social media, journalists are navigating a landscape that is [...]
The Evolving Landscape of Journalism in the Digital Age
The Evolving Landscape of Journalism in the Digital Age In recent years, the field of journalism has undergone a seismic transformation, driven largely by the advent of digital and social media. As traditional news outlets grapple with the challenges posed [...]
The Evolving Landscape of Journalism in the Digital Age: Challenges and Opportunities
In the ever-evolving world of media, journalism has seen transformative shifts driven by digital innovation and the rise of new media platforms. As traditional journalism intersects with the digital frontier, the roles, responsibilities, and reach of journalists are continually being [...]
The Evolution of Journalism in the Digital Age
In the digital era, journalism has undergone a seismic transformation, reshaping the landscape in which news is gathered, delivered, and consumed. The proliferation of digital media has not only democratised information but has also presented unique challenges and opportunities for [...]
The Evolution of Journalism in the Digital Age
In the rapidly evolving landscape of journalism, the digital age has brought about significant changes that have reshaped how news is gathered, reported, and consumed. Traditional media outlets are increasingly adapting to new technologies and platforms, while emerging digital-only publications [...]
Understanding the Modern Media Landscape: A Guide for Aspiring Journalists
The world of journalism is undergoing a seismic shift. With the advent of digital media, traditional boundaries have blurred, creating a dynamic and often unpredictable news environment. This transformation poses both challenges and opportunities for aspiring journalists seeking to make [...]
The Changing Face of Journalism
Introduction The landscape of journalism has undergone significant transformations in recent years, driven by the advent of digital media and the proliferation of social platforms. In this new era, traditional media outlets are not only competing against each other [...]
Understanding the Complex Landscape of New Media Journalism
The evolution of journalism in the digital age presents a dynamic and complex landscape. As traditional media grapples with the rapid advancements in technology, new media journalism emerges, characterized by its unique challenges and opportunities. This shift is not simply [...]
The New Media Landscape: Navigating the Complex World of Digital Journalism
In recent years, the landscape of journalism has undergone a seismic shift, driven by the emergence of digital platforms and the proliferation of social media. As traditional media outlets adapt to this new paradigm, understanding the intricacies of digital journalism [...]
The Evolution of Journalism in the Digital Age
The world of journalism has transformed dramatically over the past few decades, largely due to the rapid advancement of digital and social media platforms. This shift has redefined how news is gathered, reported, and consumed. Traditional media outlets, once the [...]
Navigating the Complex Landscape of New Media Journalism
In the rapidly evolving world of journalism, the emergence of digital media has drastically reshaped the industry. Traditional newsrooms are no longer the sole gatekeepers of information, as social media platforms and independent news websites have democratized content creation and [...]
The Evolution of Journalism in the Digital Age
As the digital landscape continues to evolve, so too does the field of journalism. The shift from traditional media to new media has brought about significant changes, impacting not only how news is gathered and disseminated, but also who qualifies [...]
An In-Depth Exploration of Journalism in the Digital Age
In the ever-evolving landscape of media, the role of journalism is undergoing a profound transformation. As the digital era progresses, traditional journalism is being reshaped by new media platforms, creating both challenges and opportunities for journalists worldwide. This article delves [...]
The Evolution of Journalism in the Digital Age: Navigating New Media Landscapes
The realm of journalism is undergoing a seismic shift as digital platforms continue to redefine the landscape of how news is produced, consumed, and monetized. As we step further into the age of new media, questions arise about who qualifies [...]
The Evolution of Journalism in the Digital Age
In the ever-evolving landscape of journalism, the digital age has revolutionized how news is gathered, disseminated, and consumed. The rise of digital media has brought both challenges and opportunities, reshaping the role of journalists and the platforms they utilize. As [...]
The Evolving Landscape of Journalism in the Digital Age
In a world where technology is constantly advancing, journalism has experienced significant transformation. With the rise of digital platforms and social media, the traditional framework of journalism has been challenged, leading to an evolution that blends new media with conventional [...]
The Evolution of Journalism in the Digital Age: Navigating New Media Challenges
In the rapidly transforming landscape of journalism, the digital age has ushered in a multitude of challenges and opportunities. As new technologies emerge and audience expectations evolve, journalists must adapt to remain relevant and impactful. This article delves into the [...]
Understanding the Evolving Landscape of New Media Journalism
In the rapidly evolving landscape of journalism, new media has emerged as a transformative force, reshaping how news is produced, distributed, and consumed. The digital age has introduced a myriad of platforms that have democratized content creation, allowing independent voices [...]
The Evolution of Journalism in the Digital Age
In the ever-evolving landscape of journalism, the digital age has brought unprecedented changes. The transformation from traditional media to digital platforms has not only reshaped how news is consumed but also how it is produced and disseminated. As we navigate [...]
The Evolution of Journalism in the Digital Age
In an era where digital transformation is influencing every facet of our lives, journalism is no exception. From the way stories are crafted to how audiences consume them, the landscape of journalism is evolving at an unprecedented pace. As new [...]
The Evolution of Journalism in the Digital Age
The journalism landscape has undergone significant transformation over the past few decades, driven primarily by the advent of digital media. The shift from traditional print to digital platforms has not only changed how news is consumed but also how it [...]
The Evolving Landscape of Journalism in the Digital Age
In the modern era, the journalism landscape is undergoing a profound transformation, driven primarily by the rise of digital media. As traditional forms of media grapple with the challenges posed by new technologies and platforms, the role of journalists and [...]
The Evolution of Journalism in the Digital Age: Navigating New Media Landscapes
In recent years, the field of journalism has undergone significant transformations with the advent of digital media. This evolution has not only altered the way news is produced and consumed but also reshaped the roles and responsibilities of journalists. As [...]
The Evolution of Journalism in the Digital Age: Navigating New Media and Freelancing
As the world becomes increasingly digital, the landscape of journalism is undergoing a radical transformation. The advent of new media has revolutionized the way news is gathered, reported, and consumed, creating both challenges and opportunities for journalists. From the rise [...]
The Evolving Landscape of Journalism: Navigating the New Digital Frontier
In recent years, the journalism industry has experienced a seismic shift due to the rapid evolution of digital media. The traditional media landscape, once dominated by newspapers and television broadcasts, has been disrupted by the rise of digital platforms and [...]
The Evolving Landscape of New Media Journalism: Challenges and Opportunities
In today's fast-paced digital world, journalism is undergoing a significant transformation. The rise of new media has reshaped the way news is produced, consumed, and disseminated. From seasoned journalists to aspiring freelancers, understanding the dynamics of this evolving landscape is [...]
The Evolution of Journalism in the Digital Age: Challenges and Opportunities
The Evolution of Journalism in the Digital Age: Challenges and Opportunities In the rapidly evolving landscape of media, the field of journalism is undergoing transformative changes. The advent of digital platforms and social media has significantly altered how news is [...]
Navigating the New Media Landscape: Challenges and Opportunities for Modern Journalists
The evolution of media in the digital age has brought significant changes to the field of journalism. With the advent of new media platforms, journalists today face a dynamic landscape that offers both unprecedented opportunities and formidable challenges. This article [...]
The Evolving Landscape of New Media Journalism
In the digital age, the field of journalism is undergoing a seismic transformation. From traditional print media to online platforms, the way news is gathered, reported, and consumed is changing at an unprecedented pace. This evolution is not just reshaping [...]
The Evolution of Journalism in the Digital Age
The field of journalism has undergone a seismic transformation with the advent of digital technology. This evolution has redefined how news is gathered, reported, and consumed, creating new opportunities and challenges for journalists worldwide. As traditional media outlets grapple with [...]
Understanding the Evolving Landscape of Journalism in the Digital Age
The world of journalism is undergoing a profound transformation, driven by the rise of digital media and the proliferation of social media platforms. This shift has not only changed how news is consumed but also how it is produced, distributed, [...]
New Media Journalism: Navigating the Modern Landscape
New Media Journalism: Navigating the Modern Landscape In today's rapidly evolving digital landscape, journalism has undergone a transformation that is as profound as it is complex. The traditional roles of journalists are being redefined by new media technologies, social media [...]
The Evolving Landscape of Journalism: Embracing the Digital Age
In an era where the digital realm dominates the media landscape, journalism is undergoing transformative changes. The emergence of new media has reshaped how news is produced, consumed, and perceived. As traditional journalism grapples with these changes, the rise of [...]
The Evolution of Journalism in the Digital Age: Challenges and Opportunities
Journalism has undergone a seismic shift in recent years, driven largely by the advent of digital technology and the rise of new media platforms. As the information landscape continues to evolve, journalists, media outlets, and the public are navigating a [...]
The Evolution of Journalism in the Digital Age: Navigating New Media Challenges
In the ever-evolving landscape of journalism, the digital age has ushered in unprecedented changes, opportunities, and challenges. As traditional newsrooms adapt to the influx of digital platforms, the role of journalists has expanded, requiring a nuanced understanding of both the [...]
Understanding the Evolution of Journalism in the Digital Age
In an era where information is both abundant and accessible at the click of a button, the landscape of journalism has undergone a seismic shift. Traditional methods of news reporting have been challenged by the advent of digital media, requiring [...]
The Evolution of Journalism in the Digital Age: Navigating New Media Landscapes
In an era defined by rapid technological advances and the pervasive influence of digital platforms, the field of journalism is undergoing a profound transformation. Traditional media outlets are being supplemented, and sometimes supplanted, by new media channels, requiring journalists to [...]
The Evolving Landscape of Journalism in the Digital Age
In the rapidly changing world of journalism, the digital age has brought about unprecedented challenges and opportunities. As traditional media outlets struggle to adapt to new technologies, the rise of digital platforms is reshaping how news is produced, distributed, and [...]
The Evolving Landscape of Journalism in the Digital Age
The journalism industry is undergoing a seismic shift, fueled by the rapid evolution of digital media. As traditional forms of news dissemination give way to new media platforms, both challenges and opportunities arise for journalists. Today, we explore the changing [...]
The Evolution of Journalism in the Digital Age: Navigating Challenges and Opportunities
In the rapidly evolving landscape of journalism, the digital age has brought forth unprecedented challenges and opportunities. As traditional media outlets strive to adapt and thrive in an era dominated by digital platforms, journalists are finding themselves at a crossroads [...]
The Evolving Landscape of Journalism in the Digital Age
The advent of digital technology has transformed the field of journalism, ushering in a new era where information is disseminated faster than ever before. As traditional media outlets grapple with declining revenues and dwindling audiences, new media platforms have emerged, [...]
The Evolution of Journalism in the Digital Age: Navigating New Media Challenges
In the ever-evolving landscape of journalism, the digital age has ushered in a plethora of challenges and opportunities that have reshaped the way news is gathered, distributed, and consumed. Traditional journalism's transition into the digital realm has been marked by [...]
The Evolving Landscape of Journalism in the Digital Age
The Evolving Landscape of Journalism in the Digital Age Journalism has undergone a seismic shift over the last two decades, with digital platforms and social media transforming how news is created, distributed, and consumed. As we navigate through the era [...]
How to Produce Winning Content in the Era of AI
The digital landscape continues to evolve rapidly, and the integration of artificial intelligence (AI) in content creation is reshaping how businesses and creators approach their strategies. As AI becomes more sophisticated, producing winning content requires an understanding of both technology [...]
Stop Wasting Money on 3 Plugins: Why “Ultimate WP Security, Cache & Translation” Is The Only Tool You Need
Is your WordPress site running slow? Are you worried about hackers? Are you missing out on global traffic because your site is only in English? Typically, solving these three problems would require installing three separate, expensive, and heavy plugins—one for [...]
Ultimate Content Streamer (UCS): Turn Your WordPress Site into a Live TV Network. Broadcast, Engage, and Monetize
Stop relying solely on third-party platforms. Learn how to broadcast, engage, and keep 100% of your ad revenue with your own website. Live streaming is no longer just a trend; it’s an essential way to connect with audiences, broadcast events, [...]
Ultimate Content Money River WordPress Plugin
WordPress AI Publishing Automation Engine Ultimate Content Money River Research, write, publish, podcast, repurpose, rotate ads, and discover winning content—automatically. Built for creators, publishers, agencies, and entrepreneurs who want consistent traffic and revenue without building a full team. ultimate-content-money-river Download [...]
Stop Selling, Start Earning: Automate Your Software Sales with the Ultimate Woocommerce Licenses Manager Plugin
If you sell software—WordPress plugins, themes, or any digital product—you know the real work begins after the sale. Managing license keys, handling activation requests, and manually sending updates is a full-time job that doesn't earn you a single extra dollar. [...]
Stop Guessing, Start Fixing: Optimize Your WordPress Code Instantly with AI
By Ultimate Multimedia Consult If you build WordPress websites, you know the anxiety. You finish a custom plugin or tweak a theme's functions.php file, and a nagging voice in your head asks: "Did I leave a security hole? Is this [...]
Navigating the Future: The Role of AI and Emerging Technologies in the Media Industry
Introduction In the rapidly evolving landscape of the media industry, technology has become a driving force, shaping how content is created, distributed, and consumed. As we step into 2024 and beyond, the integration of artificial intelligence (AI) and other emerging [...]
Harnessing AI and Emerging Technologies in the Media Industry: A 2025 Outlook
The Evolution of Media: Integrating AI and Emerging Technologies In the rapidly evolving landscape of the media industry, the integration of artificial intelligence (AI) and emerging technologies has become not just a trend, but a necessity. As audiences become more [...]
Navigating the Future: Emerging Technologies and Trends in the Media Industry
The Evolution of the Media Industry The media landscape is undergoing a seismic shift, driven by rapid technological advancements and changing consumer preferences. From traditional broadcasting to digital platforms, the way content is created, consumed, and monetized is evolving at [...]
Transforming Media with Cutting-Edge Technology: A Look Ahead
Introduction The media industry is in a state of rapid evolution, driven by technological advancements that are reshaping how content is created, consumed, and distributed. From artificial intelligence (AI) to cloud computing, these innovations are not only enhancing operational efficiency [...]
Social Media Essentials and Digital Marketing Course
In today's rapidly evolving digital landscape, social media has become a cornerstone of effective communication and marketing. As social platforms play an increasingly crucial role, both organizations and individuals can harness these tools to engage their audiences, create brand awareness, [...]
Ugandans need more information and discussion on service offers by telecom companies
A new research has called for more public scrutiny of the work, services and products of telecom companies in Uganda in order to ensure Ugandans are getting value for their money. The research tracked newspaper and online media coverage of [...]
Ugandans must rethink labour routines towards innovative work methods
As Uganda joins the rest of the world to mark International Labour Day on May 1st, 2020, the biggest percentage of the country’s labour force is grappling with uncertain future over whether they will be working gainfully in the coming [...]
Learners can study full Uganda school curriculum, be assessed on Yaaka Digital Network
Kampala: As the COVID-19 pandemic continues to keep schools closed and millions of learners home, Ultimate Multimedia Consult (UMC) has launched online classes for learners from primary one to senior six to study and be assessed based on the Uganda [...]
Laws governing Internet & Mobile Usage in Uganda
NITA is an autonomous Government parastatal under the Ministry of ICT, mandated to co-ordinate, promote and monitor Information and Technology developments in Uganda within the context of National Social and Economic development. Below are the Rules & Regulations Computer Misuse [...]
Excel with Ultimate Multimedia Consult
Ultimate Multimedia Consult (UMC) has created the capacity to deliver efficient and useful multimedia news, information and knowledge products and services from a wide spectrum of professional practitioners. We have a pool of qualified and well-motivated media and research practitioners and trainers [...]
Multimedia Services
We deliver efficient multimedia production services providing news, information, and knowledge. Whether you need small or big scale video, photo or audio documentation and productions, we have the teams to deliver what you want. You can come to us for the [...]